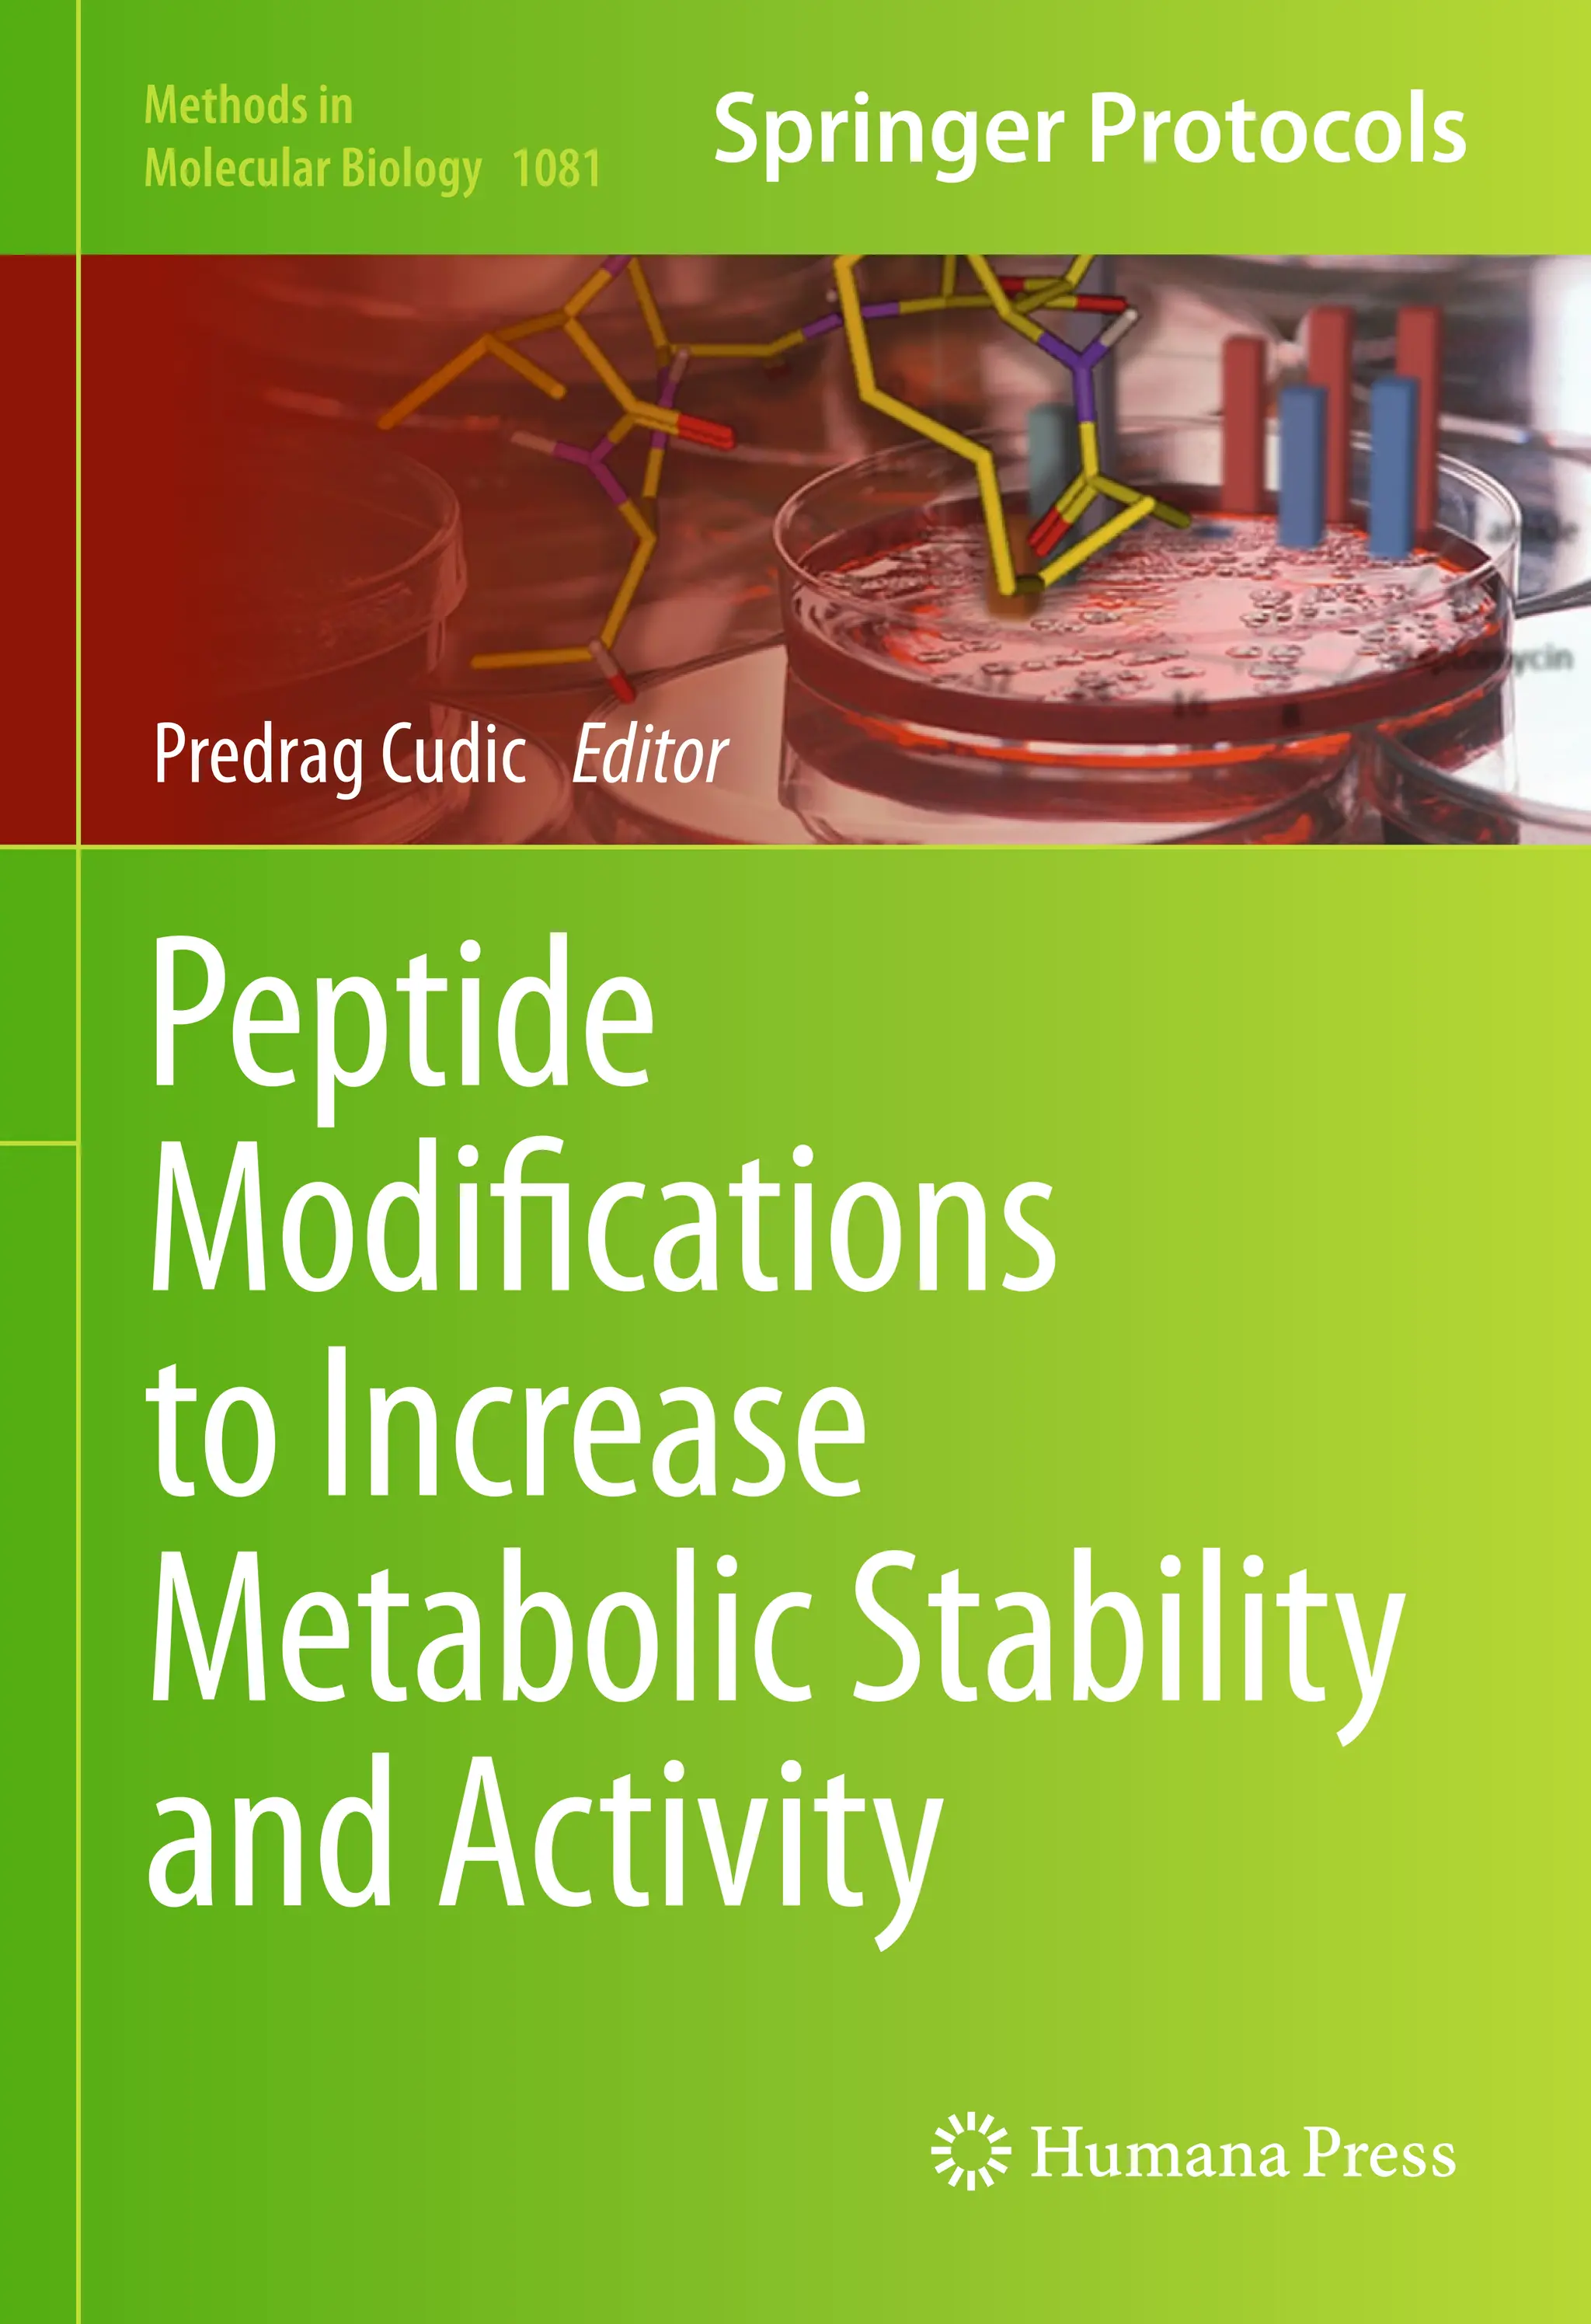
Peptide
Modifications
toIncrease
MetabolicStability
andActivity
Predrag Cudic Editor
Methods in
Molecular Biology 1081

Peptide Modifications To Increase Metabolic Stability And Activity 2013th Predrag Cudic
Peptide Modifications To Increase Metabolic Stability And Activity 2013th Predrag Cudic
Peptide Modifications To Increase Metabolic Stability And Activity 2013th Predrag Cudic

![v
Historically, natural products have served as important sources of pharmacologically active
compounds or lead structures for the development of new drugs. Among natural products,
peptides are particularly interesting because of the key roles they play in biological pro-
cesses. Peptides’ potential for high efficacy and their minimal side effects combined with
advances in recombinant DNA technology, solid-phase synthetic chemistry, purification
technology, and new strategies for peptide drug delivery made them widely considered as
lead compounds in drug development. At present around 67 peptides are in the world
market for clinical applications, some 270 are in clinical phases, and more than 400 are in
advanced preclinical trials worldwide. Peptide-based therapeutics exist for a variety of
human diseases, including osteoporosis (calcitonin), diabetes (insulin), infertility (gonad-
orelin), carcinoid tumors and acromegaly (octreotide), hypothyroidism (thyrotropin-
releasing hormone [TRH]), and bacterial infections (vancomycin, daptomycin). However,
despite their great potential, there are still limitations for peptides as drugs per se. Major
disadvantages are short half-life, rapid metabolism, and poor permeation across biological
barriers such as the blood–brain barrier (BBB) and intestinal mucosa. Nevertheless, phar-
macokinetic properties of peptides can be improved and optimized through synthetic mod-
ifications. Peptidomimetic modifications, cyclization of linear peptides, or incorporation of
D- and non-proteinogenic amino acids are traditionally used, both in academia and in
industry, as an attractive method to provide more stable and bioactive peptides. In addition,
linear peptide sequence modification by cyclization, glycosylation, and incorporation of
non-proteinogenic amino acids have been widely used to enhance the potential of peptides
as therapeutic agents. Peptide modifications to increase metabolic stability and activity is the
first volume of a series that summarizes methods for preparation and purification of these
peptides, and assessment of their biochemical activity. Readers of this volume will find
detailed synthetic protocols that lead to modifications of the peptide backbone, side chains
chapter, and terminal residues. Among these are protocols for preparation of conforma-
tionally constrained peptides (Chapters 1 and 2), modification of peptide bonds (Chapters
3 and 4), introduction of non-proteinogenic amino acids (Chapters 5–7), and alteration of
peptides’ physical and biological properties by modification of the amino acid side chains
and/or terminal residues (Chapters 8–12). Last chapter (Chapter 13) describes a new
experimental approach for the detection of exogenous peptides within living cells using
peptides labeled with heavy isotopes and confocal Raman microscopy. This method allows
peptide structure–activity relationships and metabolism to be explored directly within the
targeted cellular environment. Of course, there are many other ways to improve peptides’
metabolic stability and activity (e.g., peptide PEGylation or N-methylation of peptide bond
and/or incorporation of D-amino acids) and they are well documented in the literature.
However, my goal in this volume is to provide alternative approaches to peptide modifica-
tion that many researchers may find applicable to their specific research requirements.
Preface](https://image.slidesharecdn.com/23878694-250523104334-de39f0c8/75/Peptide-Modifications-To-Increase-Metabolic-Stability-And-Activity-2013th-Predrag-Cudic-10-2048.jpg)




![1
Predrag Cudic (ed.), Peptide Modifications to Increase Metabolic Stability and Activity, Methods in Molecular Biology, vol. 1081,
DOI 10.1007/978-1-62703-652-8_1, © Springer Science+Business Media New York 2013
Chapter 1
Hantzsch Based Macrocyclization Approach
for the Synthesis of Thiazole Containing Cyclopeptides
Adel Nefzi
Abstract
An innovative macrocyclization approach via high-yielding solid-phase intramolecular thioalkylation reac-
tion is described. The reaction of S-nucleophiles with newly generated N-terminal 4-chloromethyl thia-
zoles leads to the desired cyclic products in high purities and good yields.
Key words Cyclic peptides, Thioalkylation, Solid-phase synthesis, Parallel synthesis, 4-Chloromethyl
thiazoles
1 Introduction
Cyclic peptides have been difficult to prepare using traditional syn-
thetic methods. In order for macrocyclization to occur, the acti-
vated peptide must adopt an entropically disfavored pre-cyclization
state before forming the desired product. Conformational con-
straint by cyclization is a common approach used to restrict the
flexibility of peptides and therefore is a valuable approach to study
topographical requirements of receptors [1–6]. Cyclization of pep-
tides can provide potent and selective ligands for receptors when
appropriate conformational constraints are incorporated.
Furthermore cyclic peptides are often more stable to peptidases,
and therefore they can have improved pharmacokinetic profiles
and serve as promising lead compounds for further development
[7–13]. Macrocycles are known for their broad range of activities
including antitumor activities and antibiotic activities such as the
structurally complex vancomycin family [14, 15]. Of the various
methods of synthesizing cyclic peptides, most often the final ring-
closing reaction is a lactamization, a lactonization (depsipeptides), or
the formation of a disulfide bridge. Reported approaches on the
solid-phase synthesis of macrocyclic compounds include intramolec-
ular nucleophilic substitutions [16, 17], intramolecular amide forma-
tions [18–20], disulfide formations [21–23], intramolecular Suzuki](https://image.slidesharecdn.com/23878694-250523104334-de39f0c8/75/Peptide-Modifications-To-Increase-Metabolic-Stability-And-Activity-2013th-Predrag-Cudic-15-2048.jpg)
![2
reactions [24–26], ring closing metathesis reactions [27–29], and
SNAr displacement reactions [30–33]. Of particular interest, thio-
alkylation reactions offer a facile and versatile approach to the syn-
thesis of cyclic peptides [16, 17, 34–37]. Examples of described
macrocyclizations via thioalkylation include the reaction of the
thiol group of a C-terminal cysteine with N-terminal acetyl bro-
mide or N-terminal benzyl bromide [16, 17, 34–37]. A conceptu-
ally different approach, wherein thioalkylation proceeds via Michael
addition of a thiolate anion to an α,β-unsaturated ester, has been
reported for the synthesis of cyclic thioether dipeptides [38].
Many reagents and techniques have been developed to facili-
tate the synthesis of cyclic peptides, for which the yield-limiting
step is generally the cyclization reaction. Particularly, the cycliza-
tion of tetra-, penta-, and hexapeptides in the all L-configuration
can be problematic, especially in the absence of beta-turn promot-
ing structures such as glycine, proline, or a D-amino acid [6, 39–42].
Our approach outlined in Fig. 1, was tested by performing the
parallel synthesis of various thiazole containing cyclic tetrapeptides
and pentapeptides from all L-amino acids.
An innovative thioalkylation approach toward the generation
of macrocyclic peptides following the intramolecular nucleophilic
substitution (SN2) of N terminus 4-chloro methyl thiazole pep-
tides with the thiol group of cysteine was described. The final
products are not entirely peptidic and the described newly gener-
ated macrocyclic compounds contain the thiazole ring, a pharma-
cophore present in many natural and synthetic products with a
wide range of pharmacological activities that can be well illustrated
by the large numbers of naturally occurring thiazole containing
macrocyclic compounds [43–45] and drugs in the market contain-
ing this function group [46–48]. We have also performed com-
parative computational studies of the chemical distribution of
different cyclic peptides in the chemical space. This studies show
that the prepared thiazole containing cyclic peptides occupy a dif-
ferent region in chemical space as compared to other cyclic forms.
2 Materials
1. All reagents such as 1,3-dichloroacetone, and solvents such as
dichloromethane (DCM), Dimethylformamide (DMF) were
obtained from Sigma-Aldrich (St. Louis, MO).
2. FmocNCS was obtained from ChemImpex (Wood Dale, IL).
3. Amino acids, Fmoc-isothiocyanate, piperidine, Cs2CO3, tri-
fluoroacetic acid (TFA), (But
)3SiH, diisopropylethylamine
(DIEA), p-methylbenzhydrylamine hydrochloride (MBHA⋅
HCl) resin (100–200 mesh, cross-linked with 1 % divinylben-
zene), and peptide coupling reagents such as diisopropylcar-
bodiimide (DICI), hydroxybenzotriazole (HOBt) were
Adel Nefzi](https://image.slidesharecdn.com/23878694-250523104334-de39f0c8/75/Peptide-Modifications-To-Increase-Metabolic-Stability-And-Activity-2013th-Predrag-Cudic-16-2048.jpg)

![4
obtained from Fisher Scientific (Waltham, MA), ChemImpex
and Novabiochem (San Diego, CA).
4. The ninhydrin test kit was obtained from AnaSpec
(Fremount, CA).
3 Methods
T-bags (Fig. 2) are prepared by containing solid phase resins within
polypropylene mesh material [49]. Polypropylene is chemically
inert and fairly thermally stable (to 150 °C), allowing a wide range
of chemical reactions to be used for solid phase synthesis without
affecting the bag material. Polystyrene cross-linked with 1 % divi-
nylbenzene, 100–200 mesh, is mainly used as the solid support. It
is very important that the size of the resin beads exceeds the size of
the pores of the polypropylene mesh material of the T-bags to
avoid resin loss during synthesis. Syntheses are carried out manu-
ally using polyethylene bottles.
Figure 1 illustrates the applicability of the proposed approach for
the parallel synthesis of 24 different thiazole containing macrocy-
clic peptides. Starting from resin-bound orthogonally protected
Fmoc-Cys-(Trt)-OH 1, the thiomethyl thiazolyl macrocyclic pep-
tidomimetics 6 were synthesized following stepwise Fmoc deprot-
ection [50] and standard repetitive Fmoc-amino-acid couplings
yielding the resin-bound linear tetrapeptide 2. The resulting
N-terminal free amine is treated with Fmoc-isothiocyanate.
Following Fmoc deprotection, the thioureas are treated with
1,3-dichloroacetone to afford following Hantzsch’s cycloconden-
sation [51–54] the resulting resin-bound chloro methyl thiazolyl
peptide 5. The Trt group is deprotected in the presence of 5 %TFA
in DCM and the resin is treated with a solution of Cs2CO3 in DMF
to undergo an SN2 intramolecular cyclization. The resin is cleaved
with HF/anisole and the desired thiazolyl thioether cyclic peptides
3.1 The T-Bag
Method
3.2 Simultaneous
Multiple Peptide
Synthesis: Parallel
Solid Phase Peptide
Synthesis of the
Resin-Bound Linear
Peptides
Fig. 2 Simultaneous parallel synthesis “Tea Bag”
Adel Nefzi](https://image.slidesharecdn.com/23878694-250523104334-de39f0c8/75/Peptide-Modifications-To-Increase-Metabolic-Stability-And-Activity-2013th-Predrag-Cudic-18-2048.jpg)
![5
6 are obtained in good yield and high purity. The identity of the
final products was confirmed by LC-MS and NMR spectroscopy
(see Note 1).
Preparation of T-bags for solid phase synthesis: All syntheses
were performed using p-methylbenzhydrylamine hydrochloride
(MBHA·HCl) resin (1.15 meq/g), and starting with 100 mg resin
per bag. Synthesis using the T-bag method can be performed using
either Boc [55, 56] or Fmoc [49] synthetic strategies. For all
manipulations, enough solvent should be used to cover the T-bags
(about 3–4 ml per bag containing 100 mg of resin). To enable
efficient washings and reactions, the reaction vessels (polyethylene
bottles) should be shaken vigorously, preferably through the use of
a reciprocating shaker. Thus, during a T-bag synthesis of various
sequences in parallel, the deprotection and washing steps can be
performed with all bags combined in a single polyethylene bottle
(Fig. 1). For the amino acid couplings, the bags are separated
depending on the different corresponding sequences to be pre-
pared. Following the coupling reactions, two washing cycles are
done separately before combining all the bags again for subsequent
washing and deprotection steps (see Note 2).
As outlined in Fig. 3, a 100 mg sample of MBHA⋅HCl resin
(1.15 meq/g) was contained within a sealed polypropylene mesh
bag. For the parallel synthesis of 24 different compounds:
1. Prepare 24 separate bags (24×100 mg resin, 2.76 mmol).
2. Put all bags in a polyethylene bottle.
3. Neutralize the resin with 500 ml of 5 % DIEA in DCM.
4. Decant the solution.
5. Couple L-Fmoc-Cys(Trt)-OH (3 eq, 4.85 g, 8.28 mmol)
using the conventional reagents HOBt (1.07 g, 8.28 mmol)
and DIC (1.16 ml, 8.28 mmol) in 300 ml anhydrous DMF
overnight at room temperature.
6. Decant the solution.
7. Wash the resin-bound dipeptide with DMF (3×) and DCM (3×).
8. Monitor the completion of the coupling by the ninhydrin
test [57].
3.3 Synthesis
of Resin-Bound
Cysteine 1
Fig. 3 Synthesis of p-methylbenzhydrylamine resin-bound cysteine
Hantzsch Based Macrocyclization](https://image.slidesharecdn.com/23878694-250523104334-de39f0c8/75/Peptide-Modifications-To-Increase-Metabolic-Stability-And-Activity-2013th-Predrag-Cudic-19-2048.jpg)
![6
Starting from resin-bound orthogonally protected Fmoc-Cys-
(Trt)-OH 1, the linear peptides 2 are synthesized following step-
wise Fmoc deprotection [14] and standard repetitive
Fmoc-amino-acid couplings (Fig. 4).
Following is the procedure for the preparation of one resin-
bound linear peptide:
1. Prepare one bag of resin 1 (100 mg, 0.115 mmol) in a small
polyethylene bottle.
2. Deprotect the Fmoc group with 10 ml 20 % piperidine in
DMF (2×10 min).
3. Wash the resin with 10 ml DMF (3×) and 10 ml DCM (3×).
4. Couple the first amino acid L-Fmoc-Xaa1-OH (6 eq,
0.69 mmol) in the presence of HOBt (6 eq, 0.094 g,
0.69 mmol) and DIC (6 eq, 0.101 ml, 0.69 mmol) in 10 ml
of anhydrous DMF for 2 h at room temperature.
5. Decant the solution.
6. Wash the resin-bound dipeptide with DMF (3×) and DCM (3×).
7. Monitor the completion of the coupling by the ninhydrin test.
8. Deprotect the Fmoc group with 10 ml 20 % piperidine in
DMF (2×10 min).
9. Wash the resin-bound dipeptide with DMF (3×) and DCM (3×).
10. Proceed with the coupling of the second amino acid L-FMOC-
XAA2-OH (6 eq, 0.69 mmol) using the same reaction conditions.
11. Monitor the completion of the coupling by the ninhydrin test.
12. Deprotect the Fmoc group with 10 ml 20 % piperidine in
DMF (2×10 min).
13. Wash the resin-bound dipeptide with DMF (3×) and DCM (3×).
14. Couple L-Fmoc-Xaa3-OH to the resin-bound tripeptide in the
same conditions to yield the corresponding resin-bound pro-
tected linear peptide 2.
15. Decant the solution.
16. Wash the resin-bound dipeptide with DMF (3×) and DCM (3×).
17. Monitor the completion of the coupling by the ninhydrin
test [57].
3.4 General
Procedure for the
Solid-Phase Synthesis
of Resin-Bound Linear
Peptide 2
Fig. 4 Solid phase peptide synthesis of the resin-bound linear peptides using
Fmoc-chemistry
Adel Nefzi](https://image.slidesharecdn.com/23878694-250523104334-de39f0c8/75/Peptide-Modifications-To-Increase-Metabolic-Stability-And-Activity-2013th-Predrag-Cudic-20-2048.jpg)



![10
9. Berezowska I, Lemieux C, Chung NN, Wilkes
BC, Schiller PW (2009) Dicarba analogues of
the cyclic enkephalin peptides H-Tyr-c-[D-Cys-
Gly-Phe-D9or L)-Cys]NH2 retain high opioid
activity. Chem Biol Drug Des 74: 329–334
10. Purington LC, Pogozheva ID, Traynor JR,
Mosberg HI (2009) Pentapeptides displaying
mu opioid receptor agonist and sigma opioid
receptor partial agonist/antagonist properties.
J Med Chem 52:7724–7731
11. Mollica A, Guardiani G, Davis P, Ma S, Porreca
F, Lai J, Manina L, Sobolev AP, Hruby VJ
(2007) Synthesis of stable and potent sigma/
mu opioid peptides: analogues of H-Tyr-c[D-
Cys-Gly-Phe-D-Cys]-OH by ring closing
metathesis. J Med Chem 50:3138–3142
12. Weltrowska G, Lu Y, Lemieux C, Chung NN,
Schiller PW (2004) A novel cyclic enkephalin
analogue with potent opioid antagonist activ-
ity. Bioorg Med Chem Lett 14:4731–4733
13. Mollica A, Davis P, Ma S, Porreca F, Lai J,
Hruby VJ (2006) Synthesis and biological
activity of the first cyclic biphalin analogues.
Bioorg Med Chem Lett 16:367–372
14. Driggers EM, Hale SP, Lee J, Terrett NK
(2008) The exploration of macrocycles for
drug discovery—an underexploited structural
class. Nat Rev Drug Discov 7:608–624
15. Blout ER (1981) Cyclic peptides: Past, pres-
ent, and future. Biopolymers 20:1901–1912
16. Feng Y, Pattarawarapan M, Wang Z, Burgess K
(1999) Solid-phase SN2 macrocyclization reac-
tions to form β-turn mimics. Org Lett 1:
121–124
17. Roberts KD, Lambert JN, Ede NJ, Bray AM
(2006) Efficient methodology for the cycliza-
tion of linear peptide libraries via intramolecu-
lar S-alkylation using multipin solid phase
peptide synthesis. J Pept Sci 12:525–532
18. Dixon MJ, Nathubhai A, Andersen OA, van
Aalten DMF, Eggleston IM (2009) An effi-
cient synthesis of argifin: a natural product chi-
tinase inhibitor with chemotherapeutic
potential. Org Biomol Chem 7:259–268
19. Romanovskis P, Spatola AF (1988) Preparation
of head-to-tail cyclic peptides via side-chain
attachment: implications for library synthesis. J
Pept Res 52:356
20. Alsina J, Jensen KJ, Albericio F, Barany G
(1999) Solid-phase synthesis with tris(alkoxy)
benzyl backbone amide linkage (BAL). Chem
Eur J 5:2787–2795
21. Craik DJ, Cemazar M, Daly NL (2007) The
chemistry and biology of cyclotides. Curr
Opin Drug Discov Dev 10:176–184
22. Pons M, Albericio F, Royo M, Giralt E (2000)
Disulfide bonded cyclic peptide dimers and tri-
mers: an easy entry to high symmetry peptide
frameworks. Synlett 2:172–181
23. Annis I, Chen L, Barany G (1998) Novel
solid-phase reagents for facile formation of
intramolecular disulfide bridges in peptides
under mild conditions. J Am Chem Soc
120:7226–7238
24. Feliu L, Planas M (2005) Cyclic peptides con-
taining biaryl and biaryl ether linkages. Int J
Pept Res Ther 11:53–97
25. Li P, Roller PP, Xu J (2002) Current synthetic
approaches to peptide and peptidomimetic
cyclization. Curr Org Chem 6:411–440
26. Kaiser M, Siciliano C, Assfalg-Machleidt I,
Groll M, Milbradt AG, Moroder L (2003)
Synthesis of a TMC-95A ketomethylene ana-
logue by cyclization via intramolecular Suzuki
coupling. Org Lett 5:3435–3437
27. Blackwell HE, Grubbs RH (1988) Highly effi-
cient synthesis of covalently cross-linked pep-
tide helices by ring-closing metathesis. Angew
Chem Int Ed 37:3281–3284
28. Reichwein JF, Versluis C, Liskamp RMJ (2000)
Synthesis of cyclic peptides by ring-closing
metathesis. J Org Chem 65:6187–6195
29. Boyle TP, Bremner JB, Coates J, Deadman J,
Keller PA, Pyne SG, Rhodes DI (2008) New
cyclic peptides via ring-closing metathesis reac-
tions and their anti-bacterial activities.
Tetrahedron 64:11270–11290
30. Feng Y, Burgess K (1999) Solid phase SNAr
macrocyclizations to give turn-extended-turn
peptidomimetics. Chem Eur J 5:3261–3272
31. Grieco P, Cai M, Liu L, Mayorov A, Chandler
K, Trivedi D, Lin G, Campiglia P, Novellino E,
Hruby VJ (2008) Design and microwave-
assisted synthesis of novel macrocyclic peptides
active at melanocortin receptors: discovery of
potent and selective hMC5R receptor antago-
nists. J Med Chem 51:2701–2707
32. Derbal S, Ghedira K, Nefzi A (2010) Parallel
synthesis of 19-membered ring macro-
heterocycles via intramolecular thioether for-
mation. Tetrahedron Lett 51:3607–3609
33. Giulianotti M, Nefzi A (2003) Efficient
approach for the diversity-oriented synthesis of
macro-heterocycles on solid-support.
Tetrahedron Lett 44:5307–5309
34. Jung G (1991) Lantibiotics—ribosomally syn-
thesized biologically active polypeptides con-
tainingsulfidebridgesanda,b,-didehydroamino
acids. Angew Chem Int Ed Engl 30:
1051–1068
35. Campiglia P, Gomez-Monterrey I,
Longobardo L, Lama T, Novellino E, Grieco
P (2004) A novel route to synthesize Freidinger
lactams by microwave irradiation. Tetrahedron
Lett 45:1453–1456
36. Jack RW, Jung G (2000) Lantibiotics and
microcins: polypeptides with unusual chemical
diversity. Curr Opin Chem Biol 4:310–317
Adel Nefzi](https://image.slidesharecdn.com/23878694-250523104334-de39f0c8/75/Peptide-Modifications-To-Increase-Metabolic-Stability-And-Activity-2013th-Predrag-Cudic-24-2048.jpg)
![11
37. Kaiser D, Jack RW, Jung G (1998) Lantibiotics
and microcins: novel posttranslational modifi-
cations of polypeptides. Pure Appl Chem
70:97–104
38. Crescenza A, Botta M, Corelli F, Santini A,
Tafi A (1999) Cyclic dipeptides. Synthesis of
methyl (R)-6-[(tert-butoxycarbonyl)amino]-
4,5,6,7- tetrahydro-2-methyl-5-oxo-1,4-
thiazepine-3-carboxylate and its hexahydro
analogues: elaboration of a novel dual ACE/
NEP inhibitor. J Org Chem 64:3019–3025
39. Olson GL, Bolin DR, Bonner MP, Bos M,
Cook CM, Fry DC, Graves BJ, Hatada M, Hill
DE, Kahn M, Madison VS, Rusiecki VK,
Sarabu R, Sepinwall J, Vincent GP, Voss ME
(1993) Concepts and progress in the develop-
ment of peptide mimetics. J Med Chem
36:3039–3046
40. MacDonald M, Aube J (2001) Approaches to
cyclic peptide beta-turn mimics. Curr Org
Chem 5:417–421
41. Suat Kee K, Jois SDS (2003) Design of β-turn
based therapeutic agents. Curr Pharm Des
9:1209–1212
42. Zhang J, Xiong C, Ying J, Wang W, Hruby V
(2003) Stereoselective synthesis of novel
dipeptide β-turn mimetics targeting melano-
cortin peptide receptors. J Org Lett 5:
3115–3118
43. Jin Z (2003) Muscarine, imidazole, oxazole,
and thiazole alkaloids. Nat Prod Rep 20:
584–605
44. Bertram A, Blake AJ, de Turiso F, Hannam JS,
Jolliffe KA, Pattenden G, Skae M (2003)
Concise synthesis of stereodefined, thiazole-
containing cyclic hexa- and octapeptide relatives
of the Lissoclinums, via cyclooligomerisation
reactions. Tetrahedron 59:6979–6990
45. Jin Z (2006) Imidazole, oxazole and thiazole
alkaloids. Nat Prod Rep 23:464–496
46. Aulakh VS, Ciufolini MA (2011) Total synthe-
sis and complete structural assignment of thio-
cillin I. J Am Chem Soc 133:5900–5904
47. Sanfilippo PJ, Jetter MC, Cordova R, Noe RA,
Chourmousis E, Lau CY, Wang E (1995)
Novel thiazole based heterocycles as inhibitors
of LFA-1/ICAM-1 mediated cell adhesion. J
Med Chem 38:1057–1059
48. Suzuki S, Yonezawa Y, Shin C (2004) Useful
synthesis of fragment A–C–D of a thiostrepton-
type macrocylic antibiotic, thiocilline I. Chem
Lett 33:814–815
49. Houghten RA (1985) General method for the
rapid solid-phase synthesis of larger numbers
of peptides: specificity of antigen–antibody
interaction at the level of individual amino
acids. Proc Natl Acad Sci USA 82:5131–5135
50. Fields GB, Noble RL (1999) Solid phase peptide
synthesis utilizing 9-fluorenylmethoxycarbonyl
amino acids. Int J Pept Protein Res 35:161–214
51. Hantzsch AR, Weber JH (1987) Ueber
verbindungen des thiazols pyridins der thio-
phenreihe. Ber Dtsch Chem Gen 20:
3118–3132
52. Garcia-Egido E, Wong SYF, Warrington BH
(2002) A Hantzsch synthesis of
2-aminothiazoles performed in a heated
microreactor system. Lab Chip 2:31–33
53. Lin PY, Hou RS, Wang HM, Kang IJ, Chen
LC (2009) Efficient synthesis of
2-aminothiazoles and fanetizole in liquid
PEG-400 at ambient conditions. J Chin Chem
Soc 56:455–458
54. Arutyunyan S, Nefzi A (2010) Synthesis of
chiral polyaminothiazoles. J Comb Chem
12:315–317
55. Gunnarsson K, Grehn L, Ragnarsson U (1988)
Synthesis and properties of N'-di-Ter-
butoxycarbonyl and N-benzyloxycarbonyl
tertbutoxycarbonyl amino acids. Angew Chem
Int Ed Engl 27:400–401
56. Gunnarsson K, Ragnarsson U (1990)
Preparation and properties of N'-di-
tertbutoxycarbonyl amino acids. Applicability
in the synthesis of Leu-enkephalin. Acta Chem
Scand 44:944–951
57. Kaiser E, Colescott RL, Bossinger CD, Cook
PI (1970) Color test for detection of free ter-
minal amino groups in the solid-phase synthe-
sis of peptides. Anal Biochem 34:595–598
Hantzsch Based Macrocyclization](https://image.slidesharecdn.com/23878694-250523104334-de39f0c8/75/Peptide-Modifications-To-Increase-Metabolic-Stability-And-Activity-2013th-Predrag-Cudic-25-2048.jpg)
![13
Predrag Cudic (ed.), Peptide Modifications to Increase Metabolic Stability and Activity, Methods in Molecular Biology, vol. 1081,
DOI 10.1007/978-1-62703-652-8_2, © Springer Science+Business Media New York 2013
Chapter 2
The Chemical Synthesis of α-Conotoxins and Structurally
Modified Analogs with Enhanced Biological Stability
Jayati Banerjee, Reena Gyanda, Yi-Pin Chang,
and Christopher J. Armishaw
Abstract
α-Conotoxins are peptide neurotoxins isolated from the venom ducts of carnivorous marine cone snails
that exhibit exquisite pharmacological potency and selectivity for various nicotinic acetylcholine receptor
subtypes. As such, they are important research tools and drug leads for treating various diseases of the
central nervous system, including pain and tobacco addiction. Despite their therapeutic potential, the
chemical synthesis of α-conotoxins for use in structure–activity relationship studies is complicated by
the possibility of three disulfide bond isomers, where inefficient folding methods can lead to a poor recovery
of the pharmacologically active isomer. In order to achieve higher yields of the native isomer, especially in
high-throughput syntheses it is necessary to select appropriate oxidative folding conditions. Moreover, the
poor biochemical stability exhibited by α-conotoxins limits their general therapeutic applicability in vivo.
Numerous strategies to enhance their stability including the substitution of disulfide bond with diselenide
bond and N-to-C cyclization via an oligopeptide spacer have successfully overcome these limitations. This
chapter describes methods for performing both selective and nonselective disulfide bond oxidation strate-
gies for controlling the yields and formation of α-conotoxin disulfide bond isomers, as well as methods for
the production of highly stable diselenide-containing and N-to-C cyclized conotoxin analogs.
Key words Conotoxins, Disulfide bonds, Diselenide bonds, Cyclized conotoxins
1 Introduction
Disulfide rich polypeptides isolated from venom sources have
provided researchers with a vast array of research probes for studying
a variety of neuropathological conditions such as pain, depression,
schizophrenia, and drug addiction, with enormous potential as
drug leads [1]. Of increasing interest are the conotoxins, which are
isolated from marine gastropods that inhabit tropical reef ecosys-
tems [2]. Conotoxins exhibit a small number of conserved disul-
fide bond frameworks, which give rise to very rigid and well defined
three dimensional scaffolds that project hypervariable amino acid](https://image.slidesharecdn.com/23878694-250523104334-de39f0c8/75/Peptide-Modifications-To-Increase-Metabolic-Stability-And-Activity-2013th-Predrag-Cudic-26-2048.jpg)
![14
residues thus accounting for their exquisite selectivity for different
ion-channelsandreceptorclasses[3].Amongthese,theα-conotoxins
can target different subtypes of nicotinic acetylcholine receptors
(nAChRs) with a high degree of specificity [4]. As such, they can be
used as novel subtype specific probes to map the role that nAChRs
play in the central nervous system and in the development of drug
leads for treating pain and tobacco addiction. The χ-conotoxins are
a structurally related class, which are selective norepinephrine trans-
porter inhibitors [5]. Importantly, a synthetic χ-conotoxin deriva-
tive, Xen2174, is currently undergoing phase II clinical trials as an
analgesic for treating chronic neuropathic pain [6].
α-Conotoxins consist of 12–20 amino acids that exhibit a
highly conserved cysteine framework consisting of two disulfide
bonds (Fig. 1). Residues Cys1 and Cys2 are always adjacent to
each other, with Cys4 occurring at or near the C-terminal. The
two intervening loops of amino acids are projected from the scaf-
fold between Cys2-Cys3 and Cys3-Cys4, denoted by letters “m”
and “n” respectively. The predominant disulfide bond connectivity
of naturally occurring α-conotoxins occurs between Cys[1–3, 2–4]
and is commonly referred to as the “globular” isomer. However,
two additional disulfide bond isomers are also possible, namely, the
“ribbon” (Cys[1–4, 2–3]) and “beads” (Cys[1–2, 3–4]) isomers.
While in most cases the globular isomer is the predominant bioac-
tive isomer in α-conotoxins, χ-conotoxins exhibit the ribbon
isomer in their natural bioactive form [5]. Nonetheless, nonnative
isomers of α-conotoxins have been reported to exhibit novel phar-
macological profiles. For example, the ribbon isomer of α-AuIB
has been shown to be several times more potent at rat parasympa-
thetic nAChR than the globular isomer [7]. As such, access to all
three synthetic conotoxin isomers is a valuable tool for performing
structure–activity relationship studies. With increasing use of com-
binatorial chemistry for performing accelerated structure–activity
relationship studies of α-conotoxins, high-throughput methods for
Fig. 1 Three possible disulfide bond isomers of α-conotoxins
Jayati Banerjee et al.](https://image.slidesharecdn.com/23878694-250523104334-de39f0c8/75/Peptide-Modifications-To-Increase-Metabolic-Stability-And-Activity-2013th-Predrag-Cudic-27-2048.jpg)
![15
the production of synthetic analogs and their respective disulfide
bond isomers are essential [8].
Like most other classes of peptides, α-conotoxins exhibit poor
biochemical stability and resistance to proteolytic degradation,
resulting in a short biological half-life that limits their general
applicability as therapeutics. Furthermore, the disulfide bonds in
α-conotoxins are inherently unstable and can undergo reduction
or scrambling to other isomers under biological reducing condi-
tions encountered in vivo [9]. Engineering conotoxin analogs with
higher biochemical stability has proven to be very effective in
slowing down the process of degradation in human serum and
extending their biological half-life in vivo.
This chapter describes common methods for accessing synthetic
isomers of α-conotoxins, as well as engineering highly stable
analogs for use in structure–activity relationship studies. Such
strategies that will be addressed include substitution of disulfide
bonds with non-reducible diselenide bonds, and N-to-C backbone
cyclization. Although the methods here describe the synthesis of
α-conotoxins, they can be readily applied to any class of disulfide
rich peptides.
2 Materials
1. All syntheses are performed manually as previously described
using either a glass peptide synthesis vessel with a fritted filter,
screw cap, and PTFE stop-cock (VWR, Radnor PA) [10], or
tea bags prepared from 74 μM polypropylene mesh (Spectrum,
Houston TX) using an impulse sealer as previously described
(see Note 1) [11].
2. Unless otherwise indicated, 4-methylbenzyl-1-yl (MBHA)
polystyrene resin (Chem-Impex, Wood Dale IL) is used for all
syntheses.
3. 2-(1H-benzotriazole-1-yl)-1,1,3,3-tetramethyluroniumhexafl
uorophosphate (HBTU) (ChemPep, Miami FL).
4. Dichloromethane (DCM), dimethylformamide (DMF), iso-
propanol (IPA), methanol, acetonitrile and trifluoroacetic acid
(TFA) (Sigma-Aldrich, St. Louis MO). All solvents are reagent
grade and are used without further purification.
5. Nα
-tert-butyloxycarbonyl (Boc) amino acids with the following
side chain protecting groups: Asn and Gln, xanthanyl (Xan); Asp
and Glu, O-cyclohexyl (OcHxl); Arg and His, p-toluenesulfonyl
(Tos); Cys, 4-methylbenzyl (MeBzl) or acetomidomethyl
(Acm); Lys, 2-chlorobenzyloxycarbonyl (ClZ); Ser, Hyp and
Thr, benzyl (Bzl); Tyr, 2-bromobenzyloxycarbonyl (BrZ); Trp,
N-formyl (For) (Chem-Impex).
2.1 General
Requirements for
Peptide Synthesis
Synthesis of α-Conotoxins and Stable Analogs](https://image.slidesharecdn.com/23878694-250523104334-de39f0c8/75/Peptide-Modifications-To-Increase-Metabolic-Stability-And-Activity-2013th-Predrag-Cudic-28-2048.jpg)
![16
6. N,N-Diisopropylethylamine (DIEA) (Chem-Impex).
7. Anhydrous hydrogen fluoride (HF) (Airgas, La Porte TX) and a
specialized HF cleavage apparatus constructed of corrosion resis-
tant material (Peptides International, Louisville KY) [12, 13].
8. Scavengers for HF cleavage as follows: p-cresol, p-thiocresol,
dimethylsulfide (DMS) and 1,2-ethanedithiol (EDT) (Sigma-
Aldrich).
1. A liquid chromatography mass spectrometer (LC-MS)
(Shimadzu, Kyoto, Japan) is used to assess the molecular
weight and purity of crude and purified peptide products, and
to assess the completion of oxidation reactions. Analytical
LC-MS is performed using a Jupiter, 50 mm×4.6 mm ID
reversed phase C18 HPLC column (Phenomenex, Torrance
CA). Buffer “A” 0.05 % aqueous formic acid; Buffer “B” 95 %
acetonitrile, 5 % water, 0.05 % formic acid; Linear gradient,
0–60 % over 12 min; Flow rate 0.5 mL/min.
2. Peptides are purified using a preparative HPLC system (Waters,
Milford MA) using a Luna, 150 mm×21.2 mm ID reversed
phase C18 HPLC column (Phenomenex); Buffer “A” 0.1 %
aqueous TFA; Buffer “B” 95 % acetonitrile, 5 % water, 0.1 %
TFA; Linear gradient; 0–40 % or 0–60 % “B” over 40 min.
Flow rate 20 mL/min. Detection wavelength 214 nm. The
product peak is fractionated and the purity analyzed by LC-MS.
3. CD spectra are recorded using a J-720 spectropolarimeter
(Jasco, Easton MD) using a 400 μL photometer cell with a
1 mm path length. Spectra are recorded between 190 and
260 nm, with an average of 4 scans.
1. 0.1 M Ammonium bicarbonate. Prepared by dissolving ammo-
nium bicarbonate (7.91 g) in 1 L deionized water and then
adjusting the pH with 1 M HCl or NH4OH as required.
2. 0.1 M Ammonium acetate. Prepared by dissolving ammonium
acetate (7.71 g) in 1 L deionized water and then adjusting the
pH with glacial acetic acid or NH4OH as required.
1. 80 % Methanol in deionized water (v/v).
2. 0.1 M HCl solution.
3. 0.1 M Na2S2O3 solution. Prepared by dissolving Na2S2O3
(1.58 g) in 100 mL deionized water.
4. 0.1 M Iodine in methanol. Prepared by dissolving elemental
iodine (0.253 g) in 10 mL of methanol.
1. Metallic selenium powder, NaBH4, NH4NH2⋅HCl, celite,
α-bromo-p-xylene, K2CO3, MgSO4 and tert-butyloxycarbonyl
dicarbonate (Sigma-Aldrich).
2. L-β-chloroalanine (Bachem, Bubendorf, Switzerland).
2.2 Analysis
and Purification
2.3 Oxidation
of Conotoxins
2.3.1 Preparation
of Oxidation Buffers
2.3.2 Iodine Mediated
Oxidation of Conotoxins
2.4 Selenocysteine
Directed Folding
2.4.1 Synthesis of
Boc–Sec[MeBzl]OH
Jayati Banerjee et al.](https://image.slidesharecdn.com/23878694-250523104334-de39f0c8/75/Peptide-Modifications-To-Increase-Metabolic-Stability-And-Activity-2013th-Predrag-Cudic-29-2048.jpg)
![17
1. Fmoc-SCAL Linker (Chem Impex) and aminomethyl
ChemMatrixresin(BioMatrix,Saint-JeanSur-Richelieu,Quebec).
2. NH4I (Sigma-Aldrich).
3. 0.1 M Ammonium formate, pH 4.2. Prepared by dissolving
ammonium formate (6.31 g) in 1 L deionized water, then
adjusting the pH with formic acid or NH4OH as required.
1. S-trityl-β-mercaptopropionyl MBHA resin (Peptides
International).
2. 0.1 M Phosphate buffer, pH 8.2. Prepared by slowly adding
0.1 M sodium phosphate (dibasic) to 0.1 M sodium phosphate
(monobasic) while monitoring with a pH meter as required.
0.1 M Phosphate buffer (dibasic) is prepared by dissolving
Na2HPO4 (14.2 g) in 1 L deionized water. 0.1 M Phosphate
buffer (monobasic) is prepared by dissolving NaH2PO4
(11.9 g) in 1 L deionized water.
3 Methods
All of the procedures described in this chapter use the Boc-chemistry
approach. However, the Fmoc-chemistry approach may be used
with equal effectiveness where indicated. For detailed procedures
on solid phase peptide synthesis using both Boc or Fmoc chemistry,
readers are referred to refs. [14, 15].
1. 55 % TFA in DCM (v/v) is used for the stepwise removal of
the Nα-Boc protecting group.
2. For syntheses using tea bags, batch washes with DCM (2×),
IPA (2×) and DCM (2×) are used following Boc deprotection.
Prior to coupling, the tea bags are neutralized using 5 %
DIEA/DCM (v/v) (3×), followed by additional washes with
DCM (3×) and DMF (3×).
3. For syntheses using a glass peptide synthesis vessel, in situ
neutralization procedures and flow washes with DMF are used
as previously described [15, 16].
4. For all syntheses, HBTU and DIEA are used to activate the
amino acid prior to coupling. DMF is used as the coupling
solvent.
5. Coupling reactions are monitored using the quantitative
ninhydrin assay [17].
6. HF cleavage reactions are performed using either a two-step
“low-high,” or a one step “high” HF cleavage procedure as
indicated for each method. For the low HF cleavage, tea bags
containing peptide-resin are treated with “low” HF cleavage
cocktail (25 % HF, 60 % DMS, 10 % p-cresol, and 5 %
EDT (v/v/v/v)) for 2 h at 0 °C. The HF cleavage cocktail is
2.4.2 Synthesis of
Diselenide Containing
Conotoxins
2.5 Cyclized
Conotoxin Analogs
3.1 General Boc
Solid Phase Peptide
Synthesis Procedure
Synthesis of α-Conotoxins and Stable Analogs](https://image.slidesharecdn.com/23878694-250523104334-de39f0c8/75/Peptide-Modifications-To-Increase-Metabolic-Stability-And-Activity-2013th-Predrag-Cudic-30-2048.jpg)
![18
discarded and the tea bags are washed alternately with DCM
and IPA (6×), then alternately with DMF and DCM (6×), and
finally with methanol (6×) before drying under high vacuum.
7. For the “high” HF cleavage, peptide-resin is cleaved (95 %
HF, 5 % p-cresol (v/v)) for 2 h at 0 °C. Following cleavage,
the HF is evaporated and the peptide is precipitated with cold
diethyl ether, centrifuged for 1 min (or filtered) and then
washed again with additional diethyl ether. The peptide is then
extracted with 95 % acetic acid/5 % H2O (v/v) and lyophilized
(see Note 2).
The use of orthogonal protecting groups on each pair of cysteine
residues can direct the formation of the desired target disulfide
bond isomer (Fig. 2). For this approach, the S-acetomidomethyl
(Acm) in combination with S-methylbenzyl (MeBzl) is widely
employed for Boc chemistry. Similarly, the S-triphenylmethyl
(Trityl, Trt) protecting group can be used with equal effectiveness
for Fmoc-chemistry. The Acm protecting group is particularly ver-
satile since deprotection and oxidation occurs simultaneously using
iodine as the oxidation reagent [18, 19]. However, sensitive side
chain residues, in particular Met and Trp are vulnerable to side
reactions, which include oxidation of methionine or formation of
tryptophan 2-thioether [20]. Depending on the extent of trypto-
phan 2-thioether formation, the use of Trp[For] with Boc chemis-
try can prevent this side reaction; however, this requires an
additional deprotection and purification step (see Note 3) and may
decrease the final yield [21].
1. Assemble the linear precursor conotoxin using orthogonal
Boc-Cys[Acm]-OH and Boc-Cys[MeBzl]-OH on each pair of
cysteine residues. Cleave from the resin using the “low-high”
HF procedure and lyophilize (for peptides containing
Trp[For], see Note 3).
2. Check the quality of the crude sample using LC-MS. If the
sample purity is sufficiently high (>80 %), proceed to the next
step. Otherwise, prior purification by preparative RP-HPLC
may be required.
3. Dissolve the reduced precursor conotoxin in 100 mL of 0.1 M
ammonium bicarbonate, pH 8.2. Up to 50 % organic co-solvent
(e.g., isopropanol or methanol) may be added to aid dissolu-
tion. For particularly hydrophobic sequences, or those that are
sensitive to basic conditions (e.g., sequences containing Asn,
Gly, or Trp[For]), dissolve the peptide in 0.1 M ammonium
acetate, pH 5.8 containing up to 30 % dimethylsulfoxide
(DMSO). Agitate for 24 h using either a magnetic stirrer plate,
or an orbital shaker platform (for parallel oxidation of multiple
samples) in an open vessel (see Note 4). Monitor the progress
of the reaction by analytical LC-MS.
3.2 Directed
Formation of
Disulfide Bonds
Jayati Banerjee et al.](https://image.slidesharecdn.com/23878694-250523104334-de39f0c8/75/Peptide-Modifications-To-Increase-Metabolic-Stability-And-Activity-2013th-Predrag-Cudic-31-2048.jpg)

![20
protected peptide using a HPLC gradient. Alternatively, samples
can be evaporated to dryness and redissolved in a smaller vol-
ume (<5 mL) for injection using an autosampler. Following
purification, lyophilize the purified partially oxidized peptide.
6. Dissolve the partially oxidized purified conotoxin in 80 %
methanol to a concentration of approximately 2.5 mg/mL.
Add 1 M HCl to a final concentration of 10 mM HCl. Add 10
equivalents of I2 solution per Cys[Acm] group and stir for
5 min using a magnetic stirrer. To quench the reaction, add
0.1 M aqueous sodium thiosulfate solution until the reaction
mixture becomes colorless. Dilute the sample to <5 % metha-
nol with 0.1 % aqueous TFA prior to desalting.
7. Desalt by passing the entire sample through a C18 reversed
phase HPLC column via direct infusion and isolate the fully
oxidized peptide using a HPLC gradient.
The nondirected formation of disulfide bond isomers is a simplified
one step oxidation procedure, which is more generally applicable
to the synthesis of native α-conotoxins and their analogs (Fig. 3).
3.3 Nondirected
Formation of Disulfide
Bonds
Fig. 3 Nondirected formation of α-conotoxin disulfide bonds using random oxidation of unprotected cysteine
residues
Jayati Banerjee et al.](https://image.slidesharecdn.com/23878694-250523104334-de39f0c8/75/Peptide-Modifications-To-Increase-Metabolic-Stability-And-Activity-2013th-Predrag-Cudic-33-2048.jpg)
![21
This strategy may be performed in one step, thus it is less labor
intensive and is very useful for accelerating the high-throughput
production of conotoxin libraries. Furthermore, it leads to
increased product yields due to fewer purification steps and has
fewer propensities for side reactions.
However, a mixture of disulfide bond isomers may be obtained
in varying ratios, thus it is important to select conditions to maxi-
mize the accumulation of the native globular isomer. As such,
optimization of oxidation conditions through a series of small scale
trial oxidations may be required to obtain the desired isomer in high
yield and purity. To this end, directed formation of each disulfide
bond isomer can be carried out prior to commencing oxidation
trials, which can be used as retention time markers by analytical
RP-HPLC. Alternatively, native α-conotoxin isomers exhibit distinct
circular dichroism (CD) spectra, with a minima occurring at 222 nm
that is characteristic of a helical structure, whereas ribbon and bead
isomers exhibit a more random conformation (Fig. 4).
When designing a series of random oxidation trials, one should
consider a variety of factors, including the choice of oxidation buf-
fer, organic co-solvents, redox reagents, pH, and temperature. Each
of these factors can be investigated to obtain the best optimized
conditions for maximization of yield and purity of the final isomer
[22]. Generally, 0.1 M ammonium bicarbonate or 0.1 M ammo-
nium acetate is used as oxidation buffers due to their compatibility
with performing LC-MS analysis. In many cases, yields of native
disulfide bond isomer have been found to increase by adding up to
Fig. 4 Circular dichroism spectra of the three disulfide bond isomers of
α-conotoxin MII
Synthesis of α-Conotoxins and Stable Analogs](https://image.slidesharecdn.com/23878694-250523104334-de39f0c8/75/Peptide-Modifications-To-Increase-Metabolic-Stability-And-Activity-2013th-Predrag-Cudic-34-2048.jpg)
![22
50 % organic co-solvents such as isopropanol to the reaction mixture
[23]. Additionally, inclusion of redox reagents such as a mixture of
reduced and oxidized glutathione have been used to mimic physi-
ological conditions to allow intermolecular disulfide interchange to
occur more rapidly [22].
1. Synthesize each of the globular, ribbon and beads isomers
using directed disulfide bond formation as described in
Subheading 3.1. Analyze by analytical RP-HPLC and record
the retention time of each isomer.
2. Assemble the linear precursor conotoxin using Boc-Cys
[MeBzl]-OH on all four cysteine residues (see Note 6). Cleave
from the resin, lyophilize and purify the reduced linear precur-
sor by preparative RP-HPLC.
3. Prepare a series of oxidation buffers to examine the effect of
buffer salt (e.g., ammonium bicarbonate or ammonium acetate),
organic co-solvents (e.g., isopropanol, methanol, ethanol, or
acetonitrile), redox reagents (e.g., reduced and oxidized gluta-
thione), pH (e.g., 6.0–9.0) and temperature (e.g., 4 °C and
ambient temperature) and time (24–72 h). Place 990 μL aliquots
of each oxidation buffer into individual 3 mL glass vials contain-
ing a magnetic stirrer flea.
4. Prepare a 10 mg/mL aqueous stock solution of purified
reduced conotoxin in deionized water. Aliquot 10 μL of cono-
toxin stock solution into each vial containing oxidation buffer
(the final concentration of conotoxin in each trial should be
0.1 mg/mL). Agitate the vials for 24–72 h using a magnetic
stirrer plate (see Note 3).
5. At various time points, remove an aliquot and quench the
oxidation by acidifying to pH 2.0 with a solution of 10 %
aqueous TFA. Analyze the reaction mixture by analytical
HPLC and compare the retention times of the products with
each isomer obtained using directed disulfide bond formation
to identify the proportion of each isomer for each condition.
1. Assemble the linear precursor conotoxin using Boc-Cys
[MeBzl]-OH on all four cysteine residues (see Note 6). Cleave
from the resin using the “low-high” HF procedure and
lyophilize.
2. Check the quality of the crude sample using LC-MS. If the
sample purity is sufficiently high (>80 %), then proceed to
the next step. Otherwise, prior purification by preparative
RP-HPLC may be required.
3. Weigh 20–50 mg of the reduced precursor conotoxin into a
125 mL Erlenmeyer or round bottom flask and dissolve in
100 mL of optimized oxidation buffer as determined from
small scale trial oxidations (see Subheading 3.2, step 1).
3.3.1 Oxidation Trials
for Optimizing α-Conotoxin
Folding
3.3.2 Large Scale
Random Oxidation
of α-Conotoxins
Jayati Banerjee et al.](https://image.slidesharecdn.com/23878694-250523104334-de39f0c8/75/Peptide-Modifications-To-Increase-Metabolic-Stability-And-Activity-2013th-Predrag-Cudic-35-2048.jpg)
![23
Agitate for 24–72 h using either a magnetic stirrer plate, or an
orbital shaker platform (for parallel oxidation of multiple
samples) in an open vessel (see Note 4). Monitor the progress
of the reaction by analytical LC-MS or analytical HPLC.
4. When judged to be complete, acidify to pH 2.0 using a
solution of 50 % aqueous TFA (2 mL). Organic co-solvents
should be first evaporated in vacuuo prior to desalting and
purification (see Note 5).
5. Desalt by passing the entire sample through a C18 reversed
phase HPLC column via direct infusion and isolate the fully
oxidized α-conotoxin using a HPLC gradient.
Although the presence of multiple disulfide bonds in α-conotoxins is
crucial for stabilizing their three dimensional conformations, they
are very prone to reduction or scrambling to other isomers by thiol
containing molecules usually found in blood plasma, which can
decrease their efficacy in vivo. Several strategies have been explored
to overcome this problem, including substitution of disulfides with
non-reducible moieties such as diselenide, lactam, thioether, or
dicarba-linkages [9, 24–26]. Among these approaches, systematic
replacement of disulfide bonds with diselenide bonds has been
shown to be the most promising for increasing stability in vivo, while
retaining pharmacological activity at the target receptors [9, 27].
Selenocysteine (Sec) is a naturally occurring amino acid, which
exhibits the propensity to oxidatively form a diselenide bond in
analogy to the disulfide bond. Diselenide bonds exhibit very simi-
lar bond geometry to disulfide bond and can be viewed as one of
the most conservative amino acid substitutions available [28].
Importantly, oxidation of selenocysteine to the corresponding dis-
elenide bond occurs much faster than cysteine at pH 5.0, allowing
selenocysteine to be selectively oxidized over cysteine at lower pH.
Furthermore, the redox potential for a mixed sulfide/selenide
bond is higher than that of a diselenide bond, suggesting that its
formation is unfavorable. As such, selenocysteine can be used to
selectively control the formation of α-conotoxin disulfide bond
isomers in a one-pot reaction without the requirement of multiple
isolation steps when appropriately incorporated into the precursor
peptide sequence (Fig. 5) [9]. Moreover, diselenide containing
α-conotoxin analogs exhibit increased resistance to reduction or
scrambling under several biological reducing conditions, including
blood plasma [9, 27].
1. Suspend metallic selenium powder (4.5 g, 57 mmol) in H2O
(25 mL) in a two-neck 250 mL round bottom flask with a
magnetic stirrer bar. Cool the flask to 0 °C in an ice/salt bath.
2. Dissolve NaBH4 (4.5 g, 119 mmol) in H2O (25 mL) and trans-
fer to a dropping funnel. Slowly add the NaBH4 solution drop
wise to the reaction mixture. After the vigorous exothermic
3.4 Selenocysteine
Directed Folding
3.4.1 Synthesis of
Boc-Sec[MeBzl]-OH
L-Selenocysteine ([Sec]2)
Synthesis of α-Conotoxins and Stable Analogs](https://image.slidesharecdn.com/23878694-250523104334-de39f0c8/75/Peptide-Modifications-To-Increase-Metabolic-Stability-And-Activity-2013th-Predrag-Cudic-36-2048.jpg)

![25
exhaust gas through two successive NaOCl traps. Filter the
reaction mixture though a celite plug to remove any excess
selenium powder. Flush the yellow filtrate with nitrogen for an
additional 1 h using a fritted Drescher bottle.
5. Carefully adjust the pH of the yellow filtrate to 6.5 using 10 M
NaOH, allowing the product to precipitate as a yellow solid.
Filter using a Buchner funnel and redissolve in minimum
volume of 2 M HCl. Filter any residual elemental selenium
and again precipitate the product by adjusting the solution to
pH 6.5 using 10 M NaOH. Filter the final amorphous yellow
product using vacuum filtration (yield 4.62 g, 70 %).
6. Characterize the product using NMR spectroscopy. 1
H NMR
(300 MHz, D2O+DCl+DSS) δ 8.2 (d, 2H), 7.9 (d, 2H), 5.1
(m, 1H), 4.8 (s, 2H), 3.9 (m, 1H), 3.1 (s, 3H).
1. Suspend L-selenocysteine (3.80 g, 9.3 mmol) in 0.5 M NaOH
(15 mL) with magnetic stirring. Cool the suspension to 0 °C
with an ice/salt bath.
2. Dissolve NaBH4 (3.60 g, 95 mmol) in H2O (15 mL) and
transfer to a dropping funnel. Add the NaBH4 solution drop
wise to the reaction vessel. After the vigorous exothermic reac-
tion has subsided and the suspension becomes colorless
(approximately 30 min), adjust the solution to pH 7.0 under
a blanket of argon using glacial acetic acid.
3. Dissolve α-bromo-p-xylene (1.11 g, 60 mmol) in ethanol
(15 mL) and add dropwise to the reaction mixture over
30 min. Stir the reaction mixture for a further 2 h at 0 °C
under argon.
4. Acidify the reaction mixture to pH 2 using 6 M HCl, which
will produce the product as a white precipitate. Filter the
product under vacuum, wash with water and then diethyl
ether. The final product is recrystallized from hot water (yield
3.50 g, 61.1 %).
5. Characterize the product using NMR spectroscopy. 1
H NMR
(300 MHz, CD3OD+D2O+DCl+DSS) δ 8.2 (d, 2H), 7.9
(d, 2H), 5.1 (m, 1H) 4.8, (s, 2H), 3.9 (m, 1H), 3.1 (s, 3H);
13C NMR (75.4 MHz, CD3OD+D2O+DCl) δ 170.7, 138.0,
136.8, 130.3, 130.1, 53.9, 28.7, 23.2, 21.4.
1. Dissolve Se-(4-methoxybenzyl)-L-selenocysteine (3.24 g,
10 mmol) together with K2CO3 (3.4 g, 0.25 mmol) in water
(25 mL) with magnetic stirring. Gently heat to aid dissolution.
2. Dissolve tert-Butyloxycarbonyl dicarbonate (2.30 g, 11 mmol)
in THF (25 mL) and add to the reaction mixture. Stir the
reaction for 1 h at room temperature.
Se-(4-methylbenzyl)-L-
selenocysteine
Boc-Sec[MeBzl]-OH
Synthesis of α-Conotoxins and Stable Analogs](https://image.slidesharecdn.com/23878694-250523104334-de39f0c8/75/Peptide-Modifications-To-Increase-Metabolic-Stability-And-Activity-2013th-Predrag-Cudic-38-2048.jpg)
![26
3. Add 100 mL of H2O to the reaction mixture and transfer to a
separating funnel. Wash the mixture with diethyl ether
(2×100 mL) and then separate the aqueous layer.
4. Acidify the aqueous layer to pH 4.0 with solid citric acid and
extract with ethyl acetate (3×100 mL). Combine the ethyl
acetate extracts and wash with 10 % citric acid (3×100 mL)
and then brine (100 mL). Dry over solid MgSO4, filter and
evaporate the solvent using a rotary evaporator. Recrystallize
the final product using petroleum spirits/diethyl ether (yield
2.8 g, 75.3 %).
5. Characterize the product using NMR spectroscopy. 1
H NMR
(300 MHz, CDCl3 +TMS) δ 7.14 (d, 2H), 7.02 (d, 2H), 5.29
(d, 2H), 3.79 (m, 2H), 2.87 (s, 2H), 2.32 (s, 3H), 1.45
(s, 9H); 13
C NMR (75.4 MHz, CDCl3) δ 175.6, 155.4, 136.6,
135.4, 129.3, 128.8, 80.5, 53.3, 28.3, 27.8, 25.3, 21.1.
1. Assemble the linear precursor conotoxin using Boc-solid phase
peptide synthesis with combinations of Boc-Sec[MeBzl]-OH
and Boc-Cys[MeBzl]-OH to achieve the desired disulfide/
diselenide bond connectivity.
2. Cleave the peptide from the resin using the high HF proce-
dure for 2 h at 0 °C.
3. Following evaporation of HF, precipitate the conotoxin with
cold ethyl acetate degassed with nitrogen. Filter and wash the
precipitated peptide with additional cold ethyl acetate.
4. The crude reduced conotoxin can be immediately dissolved in
0.1 M ammonium formate buffer (pH 4.2) containing 50 %
isopropanol to a concentration <10 mmol and stirred for 2 h
at room temperature in an open vessel.
5. Carefully adjust the pH of the solution to 8.2 using ammo-
nium hydroxide solution and continue stirring overnight at
room temperature in an open vessel. Monitor the oxidation
progress using LC-MS.
6. When the oxidation is judged to be complete, acidify the
sample to pH 2.0 using TFA. Remove the isopropanol in
vacuo (see Note 4). Desalt by passing the entire sample
through a C18 reversed phase HPLC column via direct infusion
and isolate fully oxidized selenoconotoxin using a HPLC
gradient.
On resin supported oxidation of selenocysteine containing
conotoxins can potentially be used in the parallel production of syn-
thetic combinatorial libraries of α-conotoxins [27]. In this synthesis,
the peptide is assembled on an amphiphilic resin containing a HF
stable safety catch amide linker (SCAL), thus allowing deprotection
3.4.2 General Synthesis
of Diselenide Containing
Conotoxins
3.4.3 On-Resin Oxidation
of Diselenide Containing
Conotoxins
Jayati Banerjee et al.](https://image.slidesharecdn.com/23878694-250523104334-de39f0c8/75/Peptide-Modifications-To-Increase-Metabolic-Stability-And-Activity-2013th-Predrag-Cudic-39-2048.jpg)
![27
of all side chain protecting groups using HF. This facilitates on-resin
oxidation of the disulfide/diselenide bond framework prior to cleav-
age of the fully oxidized conotoxin from the resin (Fig. 6).
1. Couple the Fmoc-SCAL linker to aminomethyl ChemMatrix®
resin containing three glycine residues as a spacer. Deprotect
with 50 % piperidine/DMF (v/v).
2. Transfer 100–500 mg of resin to 74 μm mesh polypropylene
tea bags. Assemble the linear precursor conotoxin using
Boc-solid phase peptide synthesis with combinations of Boc-
Sec[MeBzl]-OH and Boc-Cys[MeBzl]-OH to achieve the
desired disulfide/diselenide bond connectivity.
3. Deprotect the side-chain protecting groups using the “high”
HF procedure (90 % HF, 5 % p-cresol, 5 % p-thiocresol) for
2 h at 0 °C. After evaporating the HF, wash the tea bags TFA
(2×), DCM (6×), DMF (6×) and H2O (6×).
Fig. 6 On-resin selenocysteine directed folding of a α-conotoxin using a safety catch amide linker
Synthesis of α-Conotoxins and Stable Analogs](https://image.slidesharecdn.com/23878694-250523104334-de39f0c8/75/Peptide-Modifications-To-Increase-Metabolic-Stability-And-Activity-2013th-Predrag-Cudic-40-2048.jpg)
![28
4. Place the tea bags containing resin into a solution of 0.1 M
NH4HCO3, pH 8.4 (10 mL/100 mg of resin). Shake over-
night in a Nalgene container at room temperature and then
wash with methanol (6×) and dry under vacuum.
5. Remove the resin from the tea bags and weigh approximately
300 mg into a 25 mL round bottom flask. Add a solution of
NH4I (100 mg), dimethyl sulfide (200 μL), and TFA (5 mL)
to the resin and stir for 4 h at room temperature.
6. Evaporate the TFA under a stream of nitrogen. Precipitate the
peptide product with cold ethyl acetate, filter and wash with
additional ethyl acetate. Redissolve the peptide in 50 %
aqueous acetonitrile containing 0.1 % TFA and lyophilize.
Purify the final product by preparative C18 RP-HPLC.
Cyclization is an effective modification strategy to increase overall
biochemical stability of therapeutically relevant peptides in vivo.
Numerous classes of disulfide rich cyclic peptides are found in
nature which exhibit compact three-dimensional structures and
remarkable stability. These include the plant cyclotides, sunflower
trypsin inhibitor, and mammalian theta-defensins [29–31]. In view
of the superior stability offered by cyclic disulfide rich peptides,
reengineering of stable conotoxins through backbone cyclization
serves as a useful synthetic modification strategy to enhance their
in vivo stability.
N-to-C cyclization of α-conotoxins via an inert oligopeptide
spacer unit has yielded analogs with vastly improved stability than the
native toxin under biological conditions, while retaining the pharma-
cological activity of the native conotoxin (Fig. 7) [32]. This has been
attributed to the fact that cyclization leads to an overall tightening of
the peptide structure resulting in a loss of flexibility, while preserving
key structural characteristics that are crucial for maintaining
pharmacological activity [32]. As such, cyclized α-conotoxins exhibit
increased resistance towards proteolytic degradation and improved
stability in human serum. Significantly, a cyclized analog of
α-conotoxin Vc1.1 has recently shown promise as an orally available
analgesic in rodent neuropathic pain models [33].
Cyclization of conotoxins is usually achieved in mildly basic
aqueous buffer through intramolecular native chemical ligation
(NCL) reaction between an N-terminal cysteine residue and a
C-terminal thioester and subsequent rearrangement to form a pep-
tide amide bond with the regeneration of N-terminal cysteine side
chain (Fig. 8) [34]. As such, the linear thioester precursor
α-conotoxin is assembled as a cyclic permutant such that one of the
four cysteine residues occurs at the N-terminal. While there are four
potential ligation sites to consider, a convenient Gly-Cys occurs in
many α-conotoxins, which offers minimal steric hindrance and
increased reaction rates. The presence of internal disulfide bonds
has also been proposed to accelerate the cyclization process via a
3.5 Cyclized
Conotoxin Analogs
Jayati Banerjee et al.](https://image.slidesharecdn.com/23878694-250523104334-de39f0c8/75/Peptide-Modifications-To-Increase-Metabolic-Stability-And-Activity-2013th-Predrag-Cudic-41-2048.jpg)
![29
thiazip mechanism, with complete conversion to the cyclized
product occurring within minutes [35]. As such, cyclization and
oxidation can be performed using a one-pot reaction, since oxida-
tive formation of the disulfide bonds occurs at a much slower rate
than cyclization. Although numerous methods have been reported
for the production of C-terminal thioesters using Fmoc SPPS [36–
38], Boc chemistry represents the most widely applicable and
robust approach for synthesizing cyclized conotoxin analogs.
Disulfide bond formation can be achieved using either the two-step
directed strategy, or a one-pot nondirected strategy. However,
varying disulfide bond isomers may be obtained by using a nondi-
rected approach, particularly if the length of the spacer is not
optimized.
When designing cyclic α-conotoxin analogs, the length and
nature of the oligopeptide spacer spanning the N- and C-termini
must be considered. Spacers consisting of consecutive arrange-
ments of functionally inert Gly-Ala residues have proven to be
effective for enhancing the biological stability of numerous
α-conotoxins. Moreover, the use of an inert Gly-Ala linker allows
for the possibility of introducing additional functional groups to
further enhance the physical properties of cyclized conotoxins
without interfering with the pharmacophore [39]. The spacer
length must be optimized in order to achieve the correct orienta-
tion of key binding residues that form the α-conotoxin pharmaco-
phore. Additionally, the spacer length also plays an important role
in dictating the formation of disulfide bond isomers in one pot
nonselective oxidation and cyclization reactions. For example,
cyclization of α-conotoxins ImI and AuIB with three or fewer
amino acid spacers showed greater preferences towards formation
of the ribbon isomer [21, 40]. In such cases directed oxidation
strategy implementing orthogonal cysteine protection was used for
increasing the yield of the globular isomer. Therefore an important
criteria for choosing linker size will depend on the three dimen-
sional conformation of the native conotoxins and the directed
Fig. 7 N-to-C cyclization of an α-conotoxin through an inert spacer
Synthesis of α-Conotoxins and Stable Analogs](https://image.slidesharecdn.com/23878694-250523104334-de39f0c8/75/Peptide-Modifications-To-Increase-Metabolic-Stability-And-Activity-2013th-Predrag-Cudic-42-2048.jpg)
![30
oxidation approach employing orthogonal protection of two
cysteine residues can be used to obtain desired disulfide bond
isomers in major proportion.
1. Deprotect S-trityl-β-mercaptopropionyl MBHA the resin by
treating with a cocktail of 90 % TFA, 5 % H2O and 5 % triiso-
propylsilane (2×10 min treatments).
2. Assemble the conotoxin sequence as a cyclic permutant using
pairs of Boc-Cys[MeBzl]-OH and Boc-Cys[Acm]-OH to
achieve the desired disulfide bond connectivity (see Note 8).
3. Cleave the linear thioester peptide precursor from the resin
using the “high” HF procedure using 90 % HF, 10 % p-cresol
3.5.1 Preparation of
Cyclized Conotoxin Analogs
(Directed Folding
Approach)
Fig. 8 Intramolecular native chemical ligation reaction in the synthesis of cyclized
α-conotoxin analogs
Jayati Banerjee et al.](https://image.slidesharecdn.com/23878694-250523104334-de39f0c8/75/Peptide-Modifications-To-Increase-Metabolic-Stability-And-Activity-2013th-Predrag-Cudic-43-2048.jpg)
![31
(see Note 9). Check the quality of the crude sample using
LC-MS. If the sample quality is sufficiently good, proceed to
the cyclization step. Otherwise, prior purification by prepara-
tive RP-HPLC may be required.
4. Dissolve 30–50 mg of crude sample in 180 mL of 0.1 M phos-
phate buffer, pH 8.2 and shake or stir vigorously for 24–48 h
in an open vessel (see Note 4). An organic co-solvent may be
used to aid dissolution of hydrophobic peptides. Monitor the
progress of the cyclization using LC-MS.
5. When the oxidation is judged to be complete, acidify the
sample to pH 2.0 using TFA. For samples containing organic
co-solvent, remove the solvent in vacuo (see Note 5). Desalt
by passing the entire sample through a C18 reversed phase
HPLC column via direct infusion. Equilibrate the column
with buffer A and isolate the partially oxidized/partially pro-
tected peptide using a HPLC gradient.
6. Dissolve the partially oxidized peptide in 80 % methanol
containing 10 mM HCl to a concentration of 2.5 mg/mL.
Prepare a 0.1 M solution of I2 in methanol. Add 10 equiva-
lents of the I2 solution per Cys[Acm] group and stir for 5 min
using a magnetic stirrer. Add 0.1 M aqueous sodium thiosul-
fate solution until the reaction becomes colorless. Dilute the
sample to <5 % methanol prior to desalting.
7. Desalt by passing the entire sample through a C18 reversed
phase HPLC column via direct infusion and isolate the fully
oxidized cyclized conotoxin using a HPLC gradient.
4 Notes
1. Tea bags may be used to efficiently prepare large synthetic
combinatorial libraries of α-conotoxins and cyclic analogs as
previously described [8, 40]. For detailed procedures regarding
synthetic combinatorial libraries, readers are referred to [41].
2. Peptides can appear oily after lyophilization with 95 % acetic
acid. Further lyophilization with 50 % aqueous acetonitrile
containing 0.1 % TFA may be required to obtain crude solid
peptide material.
3. For sequences containing a protected Trp[For], HF cleavage
procedures using thiol scavengers should be avoided to prevent
premature removal of the formyl protecting group. As such,
the “low” HF cleavage is not compatible. To remove the for-
myl protecting group following oxidation, redissolve the
oxidized conotoxin (approximately 10 mg) in 6 M guanidine
hydrochloride (16 mL) and cool to 0 °C. Add 1 mL of etha-
nolamine and stir for 5 min at 0 °C. Acidify to pH 2 using 1 M
Synthesis of α-Conotoxins and Stable Analogs](https://image.slidesharecdn.com/23878694-250523104334-de39f0c8/75/Peptide-Modifications-To-Increase-Metabolic-Stability-And-Activity-2013th-Predrag-Cudic-44-2048.jpg)
![32
HCl, dilute to >100 mL and purify by C18 preparative
RP-HPLC.
4. The mouth of each vessel can be sealed with plastic laboratory
film and pierced with a pipette tip to allow air to permeate the
oxidation mixture while preventing foreign objects from
entering.
5. A rotary solvent evaporator can be used to evaporate co-solvents
for single samples, or an automated system can be used for
multiple samples (e.g., Genevac Rocket or Biotage V10
evaporators).
6. When using tea bags, assembly and cleavage can be performed
in parallel with the synthesis of individual isomer via the
directed synthesis strategy to increase efficiency.
7. Dropwise addition over 2 h is required to prevent selenome-
thionine formation.
8. It is crucial that a free cysteine side chain is present as the
N-terminal residue in the linear thioester precursor to allow
the internal NCL reaction to occur. As such, the location of
Cys[Acm] residues should be considered carefully to achieve
the desired disulfide bond connectivity.
9. HF cleavage procedures using thiol scavengers should be
avoided to prevent premature cleavage of the peptide via
thioester exchange. As such, the “low” HF cleavage is not
compatible with thioester peptides.
Acknowledgment
The authors acknowledge financial support by the James and Esther
King Biomedical Research Program (New Investigator Grant,
1KN02-33990), the Arthritis and Chronic Pain Research Institute,
and the State of Florida.
References
1. Lewis RJ, Garcia ML (2003) Therapeutic
potential of venom peptides. Nat Rev Drug
Discov 2:790–802
2. Han TS, Teichert RW, Olivera BM, Bulaj G
(2008) Conus venoms—a rich source of
peptide-based therapeutics. Curr Pharm Des
14:2462–2479
3. Woodward SR, Cruz LJ, Olivera BM, Hillyard
DR (1990) Constant and hypervariable regions
in conotoxin peptides. EMBO J 9:1015–1020
4. Armishaw CJ (2010) Synthetic α-conotoxin
mutants as probes for studying nicotinic
acetylcholine receptors and in the development
of novel drug leads. Toxins (Basel) 2:
1470–1498
5. Sharpe IA, Gehrmann J, Loughnan ML,
Thomas L, Adams DA, Atkins A, Palant E,
Craik DJ, Alewood PF, Lewis RJ (2001) Two
new classes of conopeptides inhibit the α1-
adrenoreceptor and noradrenaline transporter.
Nat Neurosci 4:902–907
6. Brust A, Palant E, Croker DE, Colless B,
Drinkwater R, Patterson B, Schroeder C,
Wilson D, Nielsen CK, Smith MT, Alewood D,
Alewood PF, Lewis RJ (2009) χ-Conopeptide
pharmacophore development: Toward a novel
Jayati Banerjee et al.](https://image.slidesharecdn.com/23878694-250523104334-de39f0c8/75/Peptide-Modifications-To-Increase-Metabolic-Stability-And-Activity-2013th-Predrag-Cudic-45-2048.jpg)


![35
Predrag Cudic (ed.), Peptide Modifications to Increase Metabolic Stability and Activity, Methods in Molecular Biology, vol. 1081,
DOI 10.1007/978-1-62703-652-8_3, © Springer Science+Business Media New York 2013
Chapter 3
Synthesis of AApeptides
Youhong Niu, Yaogang Hu, Haifan Wu, and Jianfeng Cai
Abstract
The creation and development of nonnatural peptidomimetics has become an area of increasing significance
in bioorganic and chemical biology. A wide range of new peptide mimics with novel structures and func-
tions are urgently needed to be explored in order to identify potential drug candidates and targeted
probes, and to study protein functions. AApeptides are a new class of peptide mimics based on chiral PNA
backbone. They are resistant to proteolytic degradation and have limitless potential for diversification.
They have been found to have a wide variety of biological applications including cellular translocation,
disruption of protein–protein interactions, formation of nanostructures, antimicrobial activity, etc. The
synthesis of AApeptides is modular and straightforward. In this chapter, methods for the synthesis of
AApeptides (including different subclasses) are described.
Key words α-AApeptides, γ-AApeptides, Solid-phase synthesis, Cyclization, Lipidation
1 Introduction
The creation of novel peptidomimetics with discrete structures
and functions has become an area of high significance in chemical
biology and biomedical sciences [1]. There has been extensive
effort in the past two decades to develop sequence-specific oligo-
mers [2, 3], including α/β-peptides [4, 5], polyamides [6], pep-
toids [7], β-peptides [8–10], γ- and δ-peptides [11–13], oligoureas
[14, 15], azapeptides [16, 17], α-aminoxy-peptides [18], sugar-
based peptides, γ- and δ-peptides [11–13], and phenylene ethyn-
ylenes [19]. These different classes of peptidomimetics are
designed through the modification of α-peptide backbone, or
introduction of peptide isosteres. As a result, they can at least
mimic peptide primary structure, as well as secondary folding
structure. It is noticeable that because of their nature of unnatural
backbone, they are often resistant to proteolytic degradation, and
are believed to have reduced immunogenicity and improved bio-
availability compared to peptides [20]. Indeed, they have begun to](https://image.slidesharecdn.com/23878694-250523104334-de39f0c8/75/Peptide-Modifications-To-Increase-Metabolic-Stability-And-Activity-2013th-Predrag-Cudic-48-2048.jpg)
![36
find some important biological and biomedical applications [21, 22].
Despite great potential, the applications of peptidomimetics are
still under developed, partially due to the limited frameworks [22].
New peptide mimics with novel structures and functions are
urgently needed to be designed and investigated [5, 22]. Such
new classes of peptidomimetics are increasingly important for the
generation of chemically diverse library for drug discovery, design
of protein/peptide mimics to study their biological functions, and
design of novel biological probes, etc. To facilitate the application
of peptidomimetics and to advance the field, we recently have
developed a new class of peptide mimics termed “AApeptides”
(Fig. 1), called so because the residues of this class of peptidomi-
metics are N-acylated-N-aminoethyl amino acids [23–30]. The
scaffold of AApeptides is organically derived from chiral PNAs;
however, unlike PNAs which are used for the mimicry of nucleic
acids, AApeptides are developed to mimic the structure and func-
tion of peptides. Depending on the position of the side chains, two
subclasses of AApeptides, α-AApeptides and γ-AApeptides were
designed and synthesized.
As shown in Fig. 1, in a unit of AApeptides, one side chain is
connected to either α- or γ-C in relation to the carbonyl group,
and the other side chain is linked to the central N through acyla-
tion. Compared with natural α-peptides, the repeating unit (build-
ing block) of AApeptides is comparable to a dipeptide residue.
As a result, AApeptides project an identical number of functional
side groups as conventional peptides of the same length [26, 30].
As such, AApeptides can presumably mimic the primary structure
and function of peptides. As half of side chains are introduced
through acylation by any carboxylic acids, the potential of devel-
oping AApeptides with chemically diverse functional groups is
limitless. In addition, half of side chains are still chiral, which may
pose conformational bias onto AApeptides, and lead to the for-
mation of certain folding structure. Similar to other classes of
peptidomimetics, AApeptides are highly resistant to protease deg-
radation [26, 30]. They are not digested by a mixture of enzymes
in 24 h [26, 30]. They also have found to have some important
Fig. 1 General structures of conventional α-peptides, α-AApeptides, and
γ-AApeptides
Youhong Niu et al.](https://image.slidesharecdn.com/23878694-250523104334-de39f0c8/75/Peptide-Modifications-To-Increase-Metabolic-Stability-And-Activity-2013th-Predrag-Cudic-49-2048.jpg)
![37
biological applications. For instance, they can mimic the structure
of p53 and disrupt cancer-related p53/MDM2 protein–protein
interactions [26, 30]. One AApeptide is able to bind to RNA with
high affinity comparable to the Tat peptide [24], demonstrating
the potential of AApeptides to mimic bioactive peptides. Two
AApeptides have also shown the capability to translocate the cel-
lular membrane with high efficiency, indicating their potential use
as drug carriers for cellular delivery of cargos [28, 29]. In addi-
tion, AApeptides have also found applications in nanotechnology.
Two AApeptides are able to form novel nanorods and nanovesi-
cles, with the morphology different from those formed from pep-
tides, which shows the potential use of AApeptides in the
development of novel nanomaterials [31]. Very recently, a few
AApeptides were designed and have shown potent and broad-
spectrum activity against a range of gram-positive and gram-nega-
tive bacteria by mimicking the structure, function and mechanisms
of antimicrobial peptides [25, 27, 32, 33]. There is no doubt that
AApeptides will have enormous biological and biomedical applica-
tions in the future.
The synthesis of AApeptides is also very straightforward, which is
expected to further facilitate their potential applications. So far the
synthetic protocols for both α-AApeptides and γ-AApeptides have
been well established, including their subclasses, such as lipidated and
cyclic forms. A general synthetic strategy can be outlined below:
1. Synthesis of AApeptide building blocks.
2. Synthesis of AApeptide sequences through the incorporation
of AApeptide building blocks.
3. Lipidation (for lipidated version) or cyclization (for cyclized
form) on solid phase.
4. Cleavage from solid support, purification by HPLC and
lyophilization.
In this chapter we will briefly describe the synthetic protocol of
α-AApeptides, γ-AApeptides, including their lipidated and cyclized
forms. As chemistry is still being developed in our lab, we envision
the synthetic procedure of AApeptides will be further evolved and
simplified in the near future.
2 Materials
1. All materials and reagents are commercially available and used
as received.
2. Organic solvents, such as ethyl acetate (EtOAc), dichlorometh-
ane (DCM), tert-butanol (t-BuOH), tetrahydrofurane (THF),
methanol (MeOH), and hexanes were ACS grade and can be
obtained from Sigma-Aldrich and Fisher. Acetonitrile was HPLC
grade and used for HPLC purification of AApeptides.
AApeptide Synthesis](https://image.slidesharecdn.com/23878694-250523104334-de39f0c8/75/Peptide-Modifications-To-Increase-Metabolic-Stability-And-Activity-2013th-Predrag-Cudic-50-2048.jpg)
![38
3. Peptide coupling reagents such as diisopropylcarbodiimide
(DIC),andbenzotriazole-1-yl-oxy-tris-pyrrolidino-phosphonium
hexafluorophosphate(PyBOP),wereobtainedfromChemImpex,
and Aksci.
4. Aminoacids(Fmoc-protected)wereobtainedfromChemImpex.
5. Resins for solid-support synthesis can be obtained from
ChemImpex and Aapptec.
3 Methods
Solid phase synthesis has been the general approach for the prepa-
ration of peptides and other natural biomacromolecules including
oligonucleotides and polysaccharides. Meanwhile, it is also the
routine strategy to generate oligomeric peptidomimetic sequences.
Since AApeptides are a new class of peptidomimetics, no synthetic
protocols have been summarized systematically. In this chapter, we
are trying to highlight some most important tips in the preparation
of AApeptides. We will first discuss the synthesis of different
subclasses of α-AApeptides (linear and lipo-linear forms), and then
we will elaborate the synthetic procedure of γ-AApeptides (linear,
cyclic, and lipo-cyclic forms).
Both canonical α-AApeptides and lipidated α-AApeptides are syn-
thesized on a Rink-amide resin using α-AApeptide building blocks.
Lipidation was achieved by capping the amino terminus of
α-AApeptides with desired fatty acids.
The general synthetic scheme of α-AApeptide building blocks is
shown in Fig. 2 [30].
3.1 Synthesis
of α-AApeptides
3.1.1 Synthesis
of α-AApeptide
Building Blocks
Fig. 2 Synthesis of α-AApeptide building blocks. (a) Fmoc-amino ethyl aldehyde,
NaBH3CN, CH3OH; (b) RCH2COOH, DhBtOH/DIC. (c) Pd/C, H2, EtOAc. DhBtOH=Ox
ohydroxybenzotriazole, DIC=Diisopropylcarbodiimide, EtOAc=Ethyl acetate
Youhong Niu et al.](https://image.slidesharecdn.com/23878694-250523104334-de39f0c8/75/Peptide-Modifications-To-Increase-Metabolic-Stability-And-Activity-2013th-Predrag-Cudic-51-2048.jpg)
![39
The typical synthetic protocol is shown as follows:
Synthesis of 2:
1. Dissolve the amino acid ester hydrochloride in methanol in a
round bottom flask.
2. Add 1.1 eq of triethylamine and stir the solution at 0 °C for
15 min.
3. Add 1 eq Fmoc-glycinaldehyde and stir the solution for
another 30 min.
4. Add 2–5 drops of acetic acid, then add 2 eq of NaBH3CN.
5. Stir the solution at 0 °C for 1 h and then at room temperature
overnight.
6. Evaporate the solvent, and wash the residue with ethyl acetate
and saturated sodium bicarbonate solution.
7. After washing the organic layer with brine for three times, dry
it over Na2SO4, and concentrate it in vacuo.
8. Purify the residue by flash chromatography.
Synthesis of 3:
1. Add compound 2, 1.2 eq of DIC, DhBtOH, and RCH2COOH
in DMF in a round bottom flask, and stir overnight.
2. Add ethyl acetate and water to the flask.
3. Separate organic layer and wash with water (3×) and Brine (2×).
4. Dry organic layer anhydrous sodium sulfate, concentrate in
vacuo, and purify by Flash chromatography.
Typical synthesis of 4:
1. Dissolve 3 in 20 ml ethyl acetate in a round bottom flask.
2. Add 10 % Pd/C and hydrogenate the solution at atmospheric
pressure overnight.
3. Evaporate the solution and purify the residue by flash
chromatography (see Note 1).
The general synthetic scheme of α-AApeptides is shown in Fig. 3 [30].
The typical synthetic protocol is shown below.
1. Place Rink-amide resin in a peptide synthesis vessel.
2. Wash the resin three times with DMF and DCM (Dichloro-
methane) and then swell in DCM.
3.1.2 Synthesis of Linear
α-AApeptides
Fig. 3 Synthesis of linear α-AApeptides. DMF=dimethylformamide
AApeptide Synthesis](https://image.slidesharecdn.com/23878694-250523104334-de39f0c8/75/Peptide-Modifications-To-Increase-Metabolic-Stability-And-Activity-2013th-Predrag-Cudic-52-2048.jpg)
![40
3. Dissolve 1.5 eq (based on the loading of the resin) α-AApeptide
building block in DMF in a vial, and add DhBtOH and DIC.
4. Add the solution to the resin in the peptide synthesis vessel,
and stir for 4 h.
5. Wash the resin three times with DMF and DCM
(Dichloromethane) and then swell in DCM (see Note 2).
6. Add 20 % Piperidine in DMF to the vessel and stir for 30 min
(see Note 3).
7. Repeat steps 2–6 until the desired sequence is synthesized on
the resin (see Note 4).
8. Transfer the resin to a vial, add TFA/TIS/H2O (95:2.5:2.5),
and incubate for 2 h (see Note 5).
9. Evaporate the solvent and purify the residue by HPLC.
The general synthetic scheme of lipidated linear α-AApeptides is
shown in Fig. 4 [32]. Lipidated linear α-AApeptides have been
found to be antimicrobial agents [32].
The typical synthetic protocol is shown below.
1. Follow the steps 1–7 of Subheading 3.1.2, until the desired
residues are assembled on the solid phase.
2. Dissolve the fatty acid in DMF in a vial, and add DIC and
DhbtOH.
3. Add the solution to the resin in the peptide synthesis vessel,
and stir for 4 h.
4. Wash the resin three times with DMF and DCM
(Dichloromethane) and then swell in DCM.
5. Transfer the resin to a vial, add TFA/TIS/H2O (95:2.5:2.5),
and incubate for 2 h (see Note 5).
6. Evaporate the solvent and purify the residue by HPLC.
Both canonical γ-AApeptides, lipidated linear γ-AApeptides and
cyclic γ-AApeptides, are synthesized on a Rink-amide resin using
γ-AApeptide building blocks. Lipidation was achieved by capping
the amino terminus of γ-AApeptides with desired fatty acids.
3.1.3 Synthesis
of Lipidated Linear
α-AApeptides
3.2 Synthesis
of γ-AApeptides
Fig. 4 Synthesis of lipidated linear α-AApeptides. AA=α-AApeptide building
blocks. CxCOOH=fatty acids
Youhong Niu et al.](https://image.slidesharecdn.com/23878694-250523104334-de39f0c8/75/Peptide-Modifications-To-Increase-Metabolic-Stability-And-Activity-2013th-Predrag-Cudic-53-2048.jpg)
![41
Cyclization was achieved on the solid support by utilizing an allyl
carboxylate ester-containing γ-AApeptide building block.
The general synthetic scheme of γ-AApeptide building blocks is
shown in Fig. 5 [26].
The typical synthetic protocol is shown as follows:
Synthesis of 6:
1. Dissolve glycine benzyl ester hydrochloride in methanol in a
round bottom flask.
2. Add 1.1 eq of triethylamine and stir the solution at 0 °C for
15 min.
3. Add 1 eq Fmoc protected amino acid aldehyde [34, 35] and
stir the solution for another 30 min.
4. Add 2–5 drops of acetic acid, then add 2 eq of NaBH3CN.
5. Stir the solution at 0 °C for 1 h and then at room temperature
overnight.
6. Evaporate the solvent, and wash the residue with ethyl acetate
and saturated sodium bicarbonate solution.
7. After washing the organic layer with brine for three times, dry
it over Na2SO4, and concentrate it in vacuo.
8. Purify the residue by flash chromatography.
Synthesis of 7:
1. Add compound 6, 1.2 eq of DIC, DhBtOH, and RCH2COOH
in DMF in a round bottom flask, and stir overnight.
2. Add ethyl acetate and water to the flask.
3. Separate organic layer and wash with water (3×) and brine (2×).
4. Dry organic layer anhydrous sodium sulfate, concentrate under
the reduced pressure, and purify by flash chromatography.
3.2.1 Synthesis
of γ-AApeptide
Building Blocks
Fig. 5 Synthesis of γ-AApeptide building blocks
AApeptide Synthesis](https://image.slidesharecdn.com/23878694-250523104334-de39f0c8/75/Peptide-Modifications-To-Increase-Metabolic-Stability-And-Activity-2013th-Predrag-Cudic-54-2048.jpg)

![President and the Collector, who are bound in friendship by other
ties than those of seaside neighborhood. The Collector was
determined to obtain the control of the Republican State Convention,
and appealed to a patriot citizen for help, who replied, that in his
judgment “it would be a delicate matter for office-holders to
undertake to dictate to the associations in the different districts who
should go from them to the State Convention, and still more delicate
to attempt to control the judgments of men employed in the
different departments as to the best men to represent them.” The
brave Collector lieutenant of the President said, “that he should not
hesitate to do it; that it was General Grant’s wish, and General Grant
was the head of the Republican Party, and should be authority on
this subject.”[146]
Plainly, the Republican Party was his perquisite, and
all Republicans were to do his bidding. From other testimony it
appears that the President, according to the statement of his
lieutenant, “wanted to be represented in the Convention,” being the
Republican State Convention of New York,—“wanted to have his
friends there in the Convention”; and the Presidential lieutenant,
being none other than the famous Collector, offered to appoint four
men in the custom-house for the witness, if he would secure the
nomination of certain persons as delegates from his district, and he
promised “that he would immediately send their names on to
Washington and have them appointed.”[147]
And so the Presidential
dictatorship was administered. Offices in the custom-house were
openly bartered for votes in the State Convention. Here was
intolerable tyranny, with demoralization like that of the slave-market.
But New York is not the only scene of this outrage. The
Presidential pretension extends everywhere; nor is it easy to
measure the arrogance of corruption or the honest indignation it
quickens into life.
PRESIDENTIAL CONTRIVANCE AGAINST SAN DOMINGO.
These Presidential pretensions, in all their variety, personal and
military, with reckless indifference to law, naturally ripened in the](https://image.slidesharecdn.com/23878694-250523104334-de39f0c8/75/Peptide-Modifications-To-Increase-Metabolic-Stability-And-Activity-2013th-Predrag-Cudic-56-2048.jpg)
![contrivance, nursed in hot-house secrecy, against the peace of the
island of San Domingo: I say deliberately, against the peace of that
island, for under the guise of annexing a portion there was menace
to the Black Republic of Hayti. This whole business, absolutely
indefensible from beginning to end, being wrong at every point, is
the special and most characteristic product of the Administration,
into which it infused and projected itself more than into anything
else. In this multiform disobedience we behold our President.
Already I have referred to this contrivance as marking an epoch in
Presidential pretensions. It is my duty now to show its true character
as a warning against its author.
A few weeks only after beginning his career as a civilian, and
while occupied with military usurpations and the perquisites of
office, he was tempted by overtures of Dominican plotters, headed
by the usurper Baez and the speculator Cazneau: the first an
adventurer, conspirator, and trickster, described by one who knows
him well as “the worst man living of whom he has any personal
knowledge”;[148]
and the second, one of our own countrymen, long
resident on the island, known as disloyal throughout the war, and
entirely kindred in character to Baez. Listening to these prompters,
and without one word in Congress or in the press suggesting
annexion of the island or any part of it, the President began his
contrivance; and here we see abuse in every form and at every step,
absolutely without precedent in our history.
The agent in this transaction was Orville E. Babcock, a young
officer figuring in the Blue Book of the time as one of the
unauthorized “secretaries” at the Executive Mansion, and also as a
major of engineers. His published instructions, under date of July 13,
1869, were simply to make inquiries; but the plot appears in a
communication of the same date from the Secretary of the Navy,
directed to the Seminole, a war-ship, with an armament of one
eleven-inch gun and four thirty-two pounders, “to give him the moral
support of its guns”; and this was followed by a telegraphic
instruction to Key West for another war-ship “to proceed without a](https://image.slidesharecdn.com/23878694-250523104334-de39f0c8/75/Peptide-Modifications-To-Increase-Metabolic-Stability-And-Activity-2013th-Predrag-Cudic-57-2048.jpg)
![moment’s delay to San Domingo City, to be placed at the disposal of
General Babcock while on that coast.”[149]
With such “moral support”
the emissary of the President obtained from the usurper Baez that
famous Protocol stipulating the annexion of Dominica to the United
States in consideration of $1,500,000, which the young officer, fresh
from the Executive Mansion, professed to execute as “Aide-de-Camp
to his Excellency General Ulysses S. Grant, President of the United
States,”—as if, instead of Chief Magistrate of a Republic, the
President were a military chieftain with his foot in the stirrup,
surrounded by a military staff. The same instrument contained the
unblushing stipulation, that “his Excellency General Grant, President
of the United States, promises, privately, to use all his influence, in
order that the idea of annexing the Dominican Republic to the
United States may acquire such a degree of popularity among
members of Congress as will be necessary for its accomplishment”:
[150]
which is simply that the President shall become a lobbyist to
bring about the annexion by Congress. Such was the strange
beginning, illegal, unconstitutional, and offensive in every particular,
but showing the Presidential character.
On his return to Washington, the young officer, who had assumed
to be “Aide-de-Camp to his Excellency General Ulysses S. Grant,” and
had bound the President to become a lobbyist for a wretched
scheme, instead of being disowned and reprimanded, was sent back
to the usurper with instructions to negotiate two treaties,—one for
the annexion of the half-island of Dominica, and the other for the
lease of the Bay of Samana.[151]
By the Constitution of the United
States “ambassadors and other public ministers” are appointed by
the President by and with the advice and consent of the Senate; but
our Aide-de-Camp had no such commission. Presidential prerogative
empowered him. Nor was naval force wanting. With three war-ships
at his disposal,[152]
he concluded negotiations with Baez and
obtained the two treaties. Naturally force was needed to keep the
usurper in power while he sold his country, and naturally such a
transaction required a Presidential Aide-de-Camp unknown to](https://image.slidesharecdn.com/23878694-250523104334-de39f0c8/75/Peptide-Modifications-To-Increase-Metabolic-Stability-And-Activity-2013th-Predrag-Cudic-58-2048.jpg)

![distant dungeon was of small moment. But this is only an
illustration. Add now the lawless occupation of the Bay of Samana
for many months after the lapse of the treaty, keeping the national
flag flying there, and assuming a territorial sovereignty which did not
exist. Then add the protracted support of Baez in his usurped power,
to the extent of placing the national flag at his disposal, and girdling
the island with our ships of war, all at immense cost, and to the
neglect of other service where the Navy was needed.
This strange succession of acts, which, if established for a
precedent, would overturn Constitution and Law, was followed by
another class of Presidential manifestations: first, an unseemly
importunity of Senators during the pendency of the treaty, visiting
the Capitol as a lobbyist, and summoning them to his presence in
squads, in obvious pursuance of the stipulation made by his Aide-de-
Camp and never disowned by him,—being intervention in the
Senate, reinforced by all the influence of the appointing power,
whether by reward or menace, all of which was as unconstitutional
in character as that warlike intervention on the island; and then,
after debate in the Senate, when the treaty was lost on solemn vote,
we were called to witness his self-willed effrontery in prosecuting the
fatal error, returning to the charge in his Annual Message at the
ensuing session, insisting upon his contrivance as nothing less than
the means by which “our large debt abroad is ultimately to be
extinguished,” and gravely charging the Senate with “folly” in
rejecting the treaty,—and yet, while making this astounding charge
against a coördinate branch of Government, and claiming such
astounding profits, he blundered geographically in describing the
prize.[153]
All this diversified performance, with its various eccentricity of
effort, failed. The report of able commissioners transported to the
island in an expensive war-ship ended in nothing. The American
people rose against the undertaking and insisted upon its
abandonment. By a message charged with Parthian shafts the
President at length announced that he would proceed no further in](https://image.slidesharecdn.com/23878694-250523104334-de39f0c8/75/Peptide-Modifications-To-Increase-Metabolic-Stability-And-Activity-2013th-Predrag-Cudic-60-2048.jpg)
![this business.[154]
His senatorial partisans, being a majority of the
Chamber, after denouncing those who had exposed the business,
arrested the discussion. In obedience to irrepressible sentiments,
and according to the logic of my life, I felt it my duty to speak; but
the President would not forgive me, and his peculiar representatives
found me disloyal to the party which I had served so long and
helped to found. Then was devotion to the President made the
shibboleth of party.
WHERE WAS THE GRAND INQUEST OF THE NATION?
Such is a summary of the San Domingo business in its
characteristic features. But here are transgressions in every form,—
open violation of the Constitution in more than one essential
requirement; open violation of International Law in more than one of
its most beautiful principles; flagrant insult to the Black Republic,
with menace of war; complicity with the wrongful imprisonment of
an American citizen; lawless assumption of territorial sovereignty in
a foreign jurisdiction; employment of the national navy to sustain a
usurper,—being all acts of substance, maintained by an agent calling
himself “Aide-de-Camp to Ulysses S. Grant, President of the United
States,” and stipulating that his chief should play the lobbyist to help
the contrivance through Congress, then urged by private appeals to
Senators, and the influence of the appointing power tyrannically
employed by the Presidential lobbyist, and finally urged anew in an
Annual Message, where undisguised insult to the Senate vies with
absurdity in declaring prospective profits and with geographical
ignorance. Such, in brief, is this multiform disobedience, where every
particular is of such aggravation as to merit the most solemn
judgment. Why the grand inquest of the nation, which brought
Andrew Johnson to the bar of the Senate, should have slept on this
conglomerate misdemeanor, every part of which was offensive
beyond any technical offence charged against his predecessor, while
it had a background of nepotism, gift-taking with official
compensation, and various Presidential pretensions beyond all](https://image.slidesharecdn.com/23878694-250523104334-de39f0c8/75/Peptide-Modifications-To-Increase-Metabolic-Stability-And-Activity-2013th-Predrag-Cudic-61-2048.jpg)

![debt of friendship, kindness, and protection due to that people, so
that instead of monitors and war-ships, breathing violence, he had
sent a messenger of peace and good-will!
This outrage was followed by an incident in which the same
sentiments were revealed. Frederick Douglass, remarkable for his
intelligence as for his eloquence, and always agreeable in personal
relations, whose only offence is a skin not entirely Caucasian, was
selected by the President to accompany the Commissioners to San
Domingo,—and yet on his return, and almost within sight of the
Executive Mansion, he was repelled from the common table of the
mail-steamer on the Potomac, where his companions were already
seated; and thus through him was the African race insulted and their
equal rights denied. But the President, whose commission he had
borne, neither did nor said anything to right this wrong, and a few
days later, when entertaining the Commissioners at the Executive
Mansion, actually forgot the colored orator whose services he had
sought.[155]
But this indignity is in unison with the rest. After insulting
the Black Republic, it is easy to see how natural it was to treat with
insensibility the representative of the African race.
ALL THESE THINGS IN ISSUE NOW.
Here I stay this painful catalogue in its various heads, beginning
with nepotism and gift-taking with repayment by office, and ending
in the contrivance against San Domingo with indignity to the African
race,—not because it is complete, but because it is enough. With
sorrow unspeakable have I made this exposure of pretensions,
which, for the sake of republican institutions, every good citizen
should wish expunged from history; but I had no alternative. The
President himself insists upon putting them in issue; he will not allow
them to be forgotten. As a candidate for reëlection he invites
judgment, while partisans acting in his behalf make it absolutely
necessary by the brutality of their assault on faithful Republicans
unwilling to see their party, like the Presidential office, a personal
perquisite. If his partisans are exacting, vindictive, and unjust, they](https://image.slidesharecdn.com/23878694-250523104334-de39f0c8/75/Peptide-Modifications-To-Increase-Metabolic-Stability-And-Activity-2013th-Predrag-Cudic-63-2048.jpg)
![act only in harmony with his nature, too truly represented in them.
There is not a ring, whether military or senatorial, that does not
derive its distinctive character from himself. Therefore, what they do
and what they say must be considered as done and said by the
chieftain they serve. And here is a new manifestation of that
sovereign egotism which no taciturnity can cover up, and a new
motive for inquiry into its pernicious influence.
THE GREAT PRESIDENTIAL QUARRELLER.
Any presentment of the President would be imperfect which did
not show how this ungovernable personality breaks forth in quarrel,
making him the great Presidential quarreller of our history. As in
nepotism, gift-taking with repayment by office, and Presidential
pretensions generally, here again he is foremost, having quarrelled
not only more than any other President, but more than all others
together, from George Washington to himself. His own Cabinet, the
Senate, the House of Representatives, the diplomatic service, and
the civil service generally, all have their victims, nearly every one of
whom, besides serving the Republican Party, had helped to make
him President. Nor have Army officers, his companions in the field,
or even his generous patrons, been exempt. To him a quarrel is not
only a constant necessity, but a perquisite of office. To nurse a
quarrel, like tending a horse, is in his list of Presidential duties. How
idle must he be, should the words of Shakespeare be fulfilled, “This
day all quarrels die”![156]
To him may be applied those other words of
Shakespeare, “As quarrellous as the weasel.”[157]
Evidently our President has never read the Eleventh
Commandment: “A President of the United States shall never
quarrel.” At least he lives in perpetual violation of it, listening to
stories from horse-cars, gobbling the gossip of his military ring,
discoursing on imaginary griefs, and nursing an unjust anger. The
elect of forty millions of people has no right to quarrel with anybody.
His position is too exalted. He cannot do it without offence to the
requirements of patriotism, without a shock to the decencies of life,](https://image.slidesharecdn.com/23878694-250523104334-de39f0c8/75/Peptide-Modifications-To-Increase-Metabolic-Stability-And-Activity-2013th-Predrag-Cudic-64-2048.jpg)
![without a jar to the harmony of the universe. If lesson were needed
for his conduct, he might find it in that king of France who on
ascending the throne made haste to declare that he did not
remember injuries received as Dauphin.[158]
Perhaps a better model
still would be Tancred, the acknowledged type of the perfect
Christian knight, who “disdained to speak ill of whoever it might be,
even when ill had been spoken of himself.”[159]
Our soldier President
could not err in following this knightly example. If this were too
much, then at least might we hope that he would consent to limit
the sphere of his quarrelsome operations so that the public service
might not be disturbed. Of this be assured,—in every quarrel he is
the offender, according to the fact, as according to every reasonable
presumption; especially is he responsible for its continuance. The
President can always choose his relations with any citizen. But he
chooses discord. With the arrogance of arms he resents any
impediment in his path,—as when, in the spring of 1870, without
allusion to himself, I felt it my duty to oppose his San Domingo
contrivance. The verse of Juvenal, as translated by Dryden,
describes his conduct:—](https://image.slidesharecdn.com/23878694-250523104334-de39f0c8/75/Peptide-Modifications-To-Increase-Metabolic-Stability-And-Activity-2013th-Predrag-Cudic-65-2048.jpg)
![“Poor me he fights,—if that be fighting where
He only cudgels and I only bear.
…
Answer or answer not, ’tis all the same,
He lays me on and makes me bear the blame.”[160]
Another scholarly translator gives to this description of the
Presidential quarrel another form, which is also applicable:—
“If that be deemed a quarrel, where, Heaven knows,
He only gives and I receive the blows;
Across my path he strides and bids me Stand!—
I bow obsequious to the dread command.”[161]
If the latter verse is not entirely true in my case, something must be
pardoned to that Liberty in which I was born.
Men take their places in history according to their deeds. The
flattery of life is then superseded by the truthful record, and rulers
do not escape judgment. Louis the Tenth of France has the
designation of Le Hutin, or “The Quarreller,” by which he is known in
the long line of French kings. And so in the long line of American
Chief-Magistrates has our President vindicated for himself the same
title. He must wear it. The French monarch was younger than our
President; but there are other points in his life which are not without
parallel. According to a contemporary chronicle, he was “well
disposed, but not very attentive to the needs of the kingdom”;[162]
and then again it was his rare fortune to sign one of the greatest
ordinances of French history, declaring that “according to the Law of
Nature every one must be born free”;[163]
but the Quarreller was in
no respect author of this illustrious act, and was moved to its
adoption by considerations of personal advantage. It will be for
impartial History to determine if our Quarreller, who treated his great
office as a personal perquisite, and all his life long was against that
Enfranchisement to which he put his name, does not fall into the
same category.](https://image.slidesharecdn.com/23878694-250523104334-de39f0c8/75/Peptide-Modifications-To-Increase-Metabolic-Stability-And-Activity-2013th-Predrag-Cudic-66-2048.jpg)

![“He is, moreover, an advocate of the One-Term
principle, as conducing toward the proper
administration of the law,—a principle with which so
many prominent Republicans have identified
themselves that it may be accepted as an article of
party faith.”
Then again, July 14th, the same organ insisted,—
“Let not Congress adjourn without passing the One-
Term Amendment to the Constitution. There has never
been so favorable an opportunity. All parties are in
favor of it.… General Grant is in favor of it. The party
which supports General Grant demands it; and above
all else public morality calls for it.”
Considering that these pledges were made by an organ of the
party, and in his very presence, they may be accepted as proceeding
from him. His name must be added to the list with Andrew Jackson,
William Henry Harrison, Henry Clay, and Benjamin F. Wade, all of
whom are enrolled against the reëligibility of a President.
But his example as President is more than his testimony in
showing the necessity of this limitation. Andrew Jackson did not
hesitate to say that it was required in order to place the President
“beyond the reach of any improper influences,” and “uncommitted to
any other course than the strict line of constitutional duty.”[164]
William Henry Harrison followed in declaring that with the adoption
of this principle “the incumbent would devote all his time to the
public interest, and there would be no cause to misrule the
country.”[165]
Henry Clay was satisfied, after much observation and
reflection, “that too much of the time, the thoughts, and the
exertions of the incumbent are occupied during his first term in
securing his reëlection.”[166]
Benjamin F. Wade, after denouncing the
reëligibility of the President, said: “There are defects in the
Constitution, and this is among the most glaring.”[167]](https://image.slidesharecdn.com/23878694-250523104334-de39f0c8/75/Peptide-Modifications-To-Increase-Metabolic-Stability-And-Activity-2013th-Predrag-Cudic-68-2048.jpg)
![And now our President by his example, besides his testimony,
vindicates all these authorities. He makes us see how all that has
been predicted of Presidents seeking reëlection is fulfilled: how this
desire dominates official conduct; how naturally the resources of the
Government are employed to serve a personal purpose; how the
national interests are subordinate to individual advancement; how all
questions, foreign or domestic, whether of treaties or laws, are
handled with a view to electoral votes; how the appointing power
lends itself to a selfish will, acting now by the temptation of office
and then by the menace of removal; and, since every office-holder
and every office-seeker has a brevet commission in the predominant
political party, how the President, desiring reëlection, becomes the
active head of three coöperating armies,—the army of office-holders,
eighty thousand strong, the larger army of office-seekers, and the
army of the political party, the whole constituting a consolidated
power which no candidate can possess without peril to his country.
Of these vast coöperating armies the President is commander-in-
chief and generalissimo. Through these he holds in submission even
Representatives and Senators, and makes the country his vassal with
a condition not unlike that of martial law, where the disobedient are
shot, while the various rings help secure the prize. That this is not
too strong appears from testimony before a Senate Committee,
where a Presidential lieutenant boldly denounced an eminent New
York citizen, who was a prominent candidate for Governor, as
“obnoxious to General Grant,”—and then, with an effrontery like the
Presidential pretension, announced that “President Grant was the
representative and head of the Republican Party, and all good
Republicans should support him in all his measures and
appointments, and any one who did not do it should be crushed
out.”[168]
Such things teach how wise were those statesmen who
would not subject the President to the temptation or even the
suspicion of using his vast powers in promoting personal ends.
Unquestionably the One-Man Power has increased latterly beyond
example,—owing partly to the greater facilities of intercourse,
especially by telegraph, so that the whole country is easily reached,](https://image.slidesharecdn.com/23878694-250523104334-de39f0c8/75/Peptide-Modifications-To-Increase-Metabolic-Stability-And-Activity-2013th-Predrag-Cudic-69-2048.jpg)
![—partly to improvements in organization, by which distant places
are brought into unity,—and partly through the protracted
prevalence of the military spirit created by the war. There was a time
in English history when the House of Commons, on the motion of
the famous lawyer Mr. Dunning, adopted the resolution, “That the
influence of the Crown has increased, is increasing, and ought to be
diminished.”[169]
The same declaration is needed with regard to the
President; and the very words of the Parliamentary patriot may be
repeated. In his memorable speech, Mr. Dunning, after saying that
he did not rest “upon proof idle to require,” declared that the
question “must be decided by the consciences of those who as a
jury were called upon to determine what was or was not within their
own knowledge.”[170]
It was on ground of notoriety cognizable to all
that he acted. And precisely on this ground, but also with specific
proofs, do I insist that the influence of the President has increased,
is increasing, and ought to be diminished. But in this excellent work,
well worthy the best efforts of all, nothing is more important than
the limitation to one term.
There is a demand for reform in the civil service, and the President
formally adopts this demand; but he neglects the first step, which
depends only on himself. From this we may judge his little
earnestness in the cause. Beyond all question Civil-Service Reform
must begin by a limitation of the President to one term, so that the
temptation to use the appointing power for personal ends may
disappear from our system, and this great disturbing force cease to
exist. If the President is sincere for reform, it will be easy for him to
set the example by declaring again his adhesion to the One-Term
principle. But even if he fails, we must do our duty.
Therefore, in opposing the prolonged power of the present
incumbent, I begin by insisting, that, for the good of the country,
and without reference to any personal failure, no President should
be a candidate for reëlection; and it is our duty now to set an
example worthy of republican institutions. In the name of the One-
Term principle, once recognized by him, and which needs no other](https://image.slidesharecdn.com/23878694-250523104334-de39f0c8/75/Peptide-Modifications-To-Increase-Metabolic-Stability-And-Activity-2013th-Predrag-Cudic-70-2048.jpg)


![senatorial committees, organized contrary to a cardinal principle of
Parliamentary Law as a cover to these scandals, testify also. And
again, let the War Department recall the disappearance of important
archives bearing on an important event of the war, so that empty
boxes remain like a coffin without a corpse. Where, then, are the
laurels? At last I find them, fresh and brilliant, in the harmony which
the President has preserved among Republicans. Harmony, do I say?
This should have been his congenial task; nor would any aid or
homage of mine have been wanting. But instead he has organized
discord, operating through a succession of rings, and for laurels we
find only weeds and thistles.
But I hear that he is successful in the States once in rebellion.
Strange that this should be said while we are harrowed by the
reports of Ku-Klux outrages. Here, as in paying the national debt,
Congress has been the effective power. Even the last extraordinary
measure became necessary, in my judgment, to supplement his little
efficiency. Had the President put into the protection of the colored
people at the South half the effort and earnest will with which he
maintained his San Domingo contrivance, the murderous Ku-Klux
would have been driven from the field and peace assured. Nor has
he ever exhibited to the colored people any true sympathy. His
conduct to Frederick Douglass on his return from San Domingo is an
illustration; and so also was his answer to the committee of colored
fellow-citizens seeking his countenance for the pending measure of
Civil Rights. Some thought him indifferent; others found him
insulting. Then came his recent letter to the great meeting at
Washington, May 9, 1872, called to assert these rights, where he
could say nothing more than this: “I beg to assure you, however,
that I sympathize most cordially in any effort to secure for all our
people, of whatever race, nativity, or color, the exercise of those
rights to which every citizen should be entitled.”[171]
Of course
everybody is in favor of “the rights to which every citizen should be
entitled.” But what are these rights? And this meaningless juggle of
words, entirely worthy of the days of Slavery, is all that is](https://image.slidesharecdn.com/23878694-250523104334-de39f0c8/75/Peptide-Modifications-To-Increase-Metabolic-Stability-And-Activity-2013th-Predrag-Cudic-73-2048.jpg)
![vouchsafed by a Republican President for the equal rights of his
colored fellow-citizens.
I dismiss the apologies with the conclusion, that in the matters to
which they invite attention his Presidency is an enormous failure.
THE PRESIDENT AS CANDIDATE.
Looking at his daily life as it becomes known through the press or
conversation, his chief employment seems the dispensation of
patronage, unless society is an employment. For this he is visited
daily by Senators and Representatives bringing distant constituents.
The Executive Mansion has become that famous “Treasury trough”
described so well by an early Congressional orator:—
“Such running, such jostling, such wriggling, such
clambering over one another’s backs, such squealing,
because the tub is so narrow and the company is so
crowded.”[172]
To sit behind is the Presidential occupation, watching and feeding
the animals. If this were an amusement only, it might be pardoned;
but it must be seen in a more serious light. Some nations are
governed by the sword,—in other words, by central force
commanding obedience. Our President governs by offices,—in other
words, by the appointing power, being a central force by which he
coerces obedience to his personal will. Let a Senator or
Representative hesitate in the support of his autocracy, or doubt if
he merits a second term, and forthwith some distant consul or
postmaster, appointed by his influence, begins to tremble. The
“Head Centre” makes himself felt to the most distant circumference.
Can such tyranny, where the military spirit of our President finds a
congenial field, be permitted to endure?
In adopting him as a candidate for reëlection we undertake to
vindicate his Presidency, and adopt in all things the insulting,
incapable, aide-de-campish dictatorship which he has inaugurated.](https://image.slidesharecdn.com/23878694-250523104334-de39f0c8/75/Peptide-Modifications-To-Increase-Metabolic-Stability-And-Activity-2013th-Predrag-Cudic-74-2048.jpg)
![Presenting his name, we vouch for his fitness, not only in original
nature, but in experience of civil life, in aptitude for civil duties, in
knowledge of republican institutions, and elevation of purpose; and
we must be ready to defend openly what he has openly done. Can
Republicans honestly do this thing? Let it be said that he is not only
the greatest nepotist among Presidents, but greater than all others
together, and what Republican can reply? Let it be said that he is not
only the greatest gift-taker among Presidents, but the only one who
repaid his patrons at the public expense, and what Republican can
reply? Let it be said that he has openly violated the Constitution and
International Law, in the prosecution of a wretched contrivance
against the peace of San Domingo, and what Republican can reply?
Let it be said, that, wielding the power of the Great Republic, he has
insulted the Black Republic with a menace of war, involving indignity
to the African Race, and what Republican can reply? Let it be said
that he has set up Presidential pretensions without number,
constituting an undoubted Cæsarism or personal government, and
what Republican can reply? And let it be added, that, unconscious of
all this misrule, he quarrels without cause even with political
supporters, and on such a scale as to become the greatest
Presidential quarreller of our history, quarrelling more than all other
Presidents together, and what Republican can reply? It will not be
enough to say that he was triumphant in war,—as Scipio, the victor
of Hannibal, reminded the Roman people that on this day he
conquered at Zama.[173]
Others have been triumphant in war and
failed in civil life,—as Marlborough, whose heroic victories seemed
unaccountable, in the frivolity, the ignorance, and the heartlessness
of his pretended statesmanship. To Washington was awarded that
rarest tribute, “First in war, first in peace, and first in the hearts of
his countrymen.”[174]
Of our President it will be said willingly, “first in
war,” but the candid historian will add, “first in nepotism, first in gift-
taking and repaying by official patronage, first in Presidential
pretensions, and first in quarrel with his countrymen.”
Anxiously, earnestly, the country asks for reform, and stands tiptoe
to greet the coming. But how expect reform from a President who](https://image.slidesharecdn.com/23878694-250523104334-de39f0c8/75/Peptide-Modifications-To-Increase-Metabolic-Stability-And-Activity-2013th-Predrag-Cudic-75-2048.jpg)











